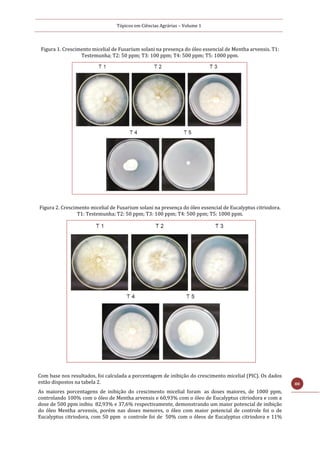
Tópicos em Ciências Agrárias – Volume 1
80
Figura 1. Crescimento micelial de Fusarium solani na presença do óleo essencial de Mentha arvensis. T1:
Testemunha; T2: 50 ppm; T3: 100 ppm; T4: 500 ppm; T5: 1000 ppm.
Figura 2. Crescimento micelial de Fusarium solani na presença do óleo essencial de Eucalyptus citriodora.
T1: Testemunha; T2: 50 ppm; T3: 100 ppm; T4: 500 ppm; T5: 1000 ppm.
Com base nos resultados, foi calculada a porcentagem de inibição do crescimento micelial (PIC). Os dados
estão dispostos na tabela 2.
As maiores porcentagens de inibição do crescimento micelial foram as doses maiores, de 1000 ppm,
controlando 100% com o óleo de Mentha arvensis e 60,93% com o óleo de Eucalyptus citriodora e com a
dose de 500 ppm inibiu 82,93% e 37,6% respectivamente, demonstrando um maior potencial de inibição
do óleo Mentha arvensis, porém nas doses menores, o óleo com maior potencial de controle foi o de
Eucalyptus citriodora, com 50 ppm o controle foi de 50% com o óleos de Eucalyptus citriodora e 11%

Este documento apresenta um resumo do volume 1 de Tópicos em Ciências Agrárias, publicado em 2019 pela Editora Poisson. O volume contém 22 capítulos discutindo diversos tópicos relacionados à agricultura e meio ambiente no Brasil, incluindo projetos de extensão rural, sistemas agroflorestais, e práticas agroecológicas.










![Tópicos em Ciências Agrárias – Volume 1
11
REFERÊNCIAS
[1] Alcântara, D. M.; Germani, G. I.; FUNDO DE PASTO: UM CONCEITO EM MOVIMENTO, Curitiba-PA, 2009.
[2] Contie, I. L; Santos, J. M.; Comunidades Tradicionais: Lutas por Terra e Território no Semiárido Brasileiro,
Porto Alegre-RS, 2015.
[3] FREIRE, P. Pedagogia do oprimido. 48ª reimpressão. Rio de Janeiro: Paz e Terra, 2009.
[4] GERMANI, G.; OLIVEIRA, G. G.Assentamentos Rurais no Médio São Francisco (Bahia Brasil): políticas públicas,
conflitos e resistências. IV Encontro Nacional da Anppas 4,5 e 6 de junho de 2008, Brasília, DF.
[5] IRPAA-Comunidades de Fundo e Fecho de Pasto tem até 2018 para se auto-reconhecerem. Disponível em: <
http://www.irpaa.org/noticias/1119/comunidades-de-fundo-e-fecho-de-pasto-tem-ate-2018-para-se-auto-
reconhecerem>. Acesso em 16 de agosto 2017.](https://image.slidesharecdn.com/topicosemcienciasagrarias-220425113627/85/Topicos-em-ciencias-agrarias-pdf-11-320.jpg)

![Tópicos em Ciências Agrárias – Volume 1
13
1 CONTEXTO
O Grupo de agroecologia Umbuzeiro – GAU, originado em 2005 é constituído por estudantes dos cursos de
Eng. Agronômica, Eng. de Bioprocessos e Biotecnologia, Direito, Pedagogia e Comunicação do Campus III,
da Universidade do Estado da Bahia-UNEB em Juazeiro-BA. O GAU através de esforços e articulações
conquistou uma sede própria, e também uma área de produção, localizada no Departamento de
Tecnologias e Ciências Sociais-DTCS/UNEB, onde coloca em prática os conhecimentos agroecológicos,
associando o saber tradicional e o científico.
Quando se reconhece a importância dos saberes tradicionais, e busca utilizar destas experiências, criam-se
novas vivências e formas de construir conhecimento contextualizado. Por isso as atividades práticas são
realizadas por meio de mutirões, sendo uma ação comum nas comunidades tradicionais. Segundo Caldeira
(apud ANDRADE, 2016, p.19):
O termo mutirão é definido como uma prática de trabalho coletivo
alicerçada em formas de cooperação de ajuda mútua, estabelecidas a
partir das relações de reciprocidade. Tal prática é desenvolvida
envolvendo relações de amizade, parentesco, vizinhança e compadrio.
Tem-se como princípio desenvolver os trabalhos compreendendo a área cultivada a partir do conceito de
agroecossistema que “é um local de produção agrícola [...] compreendido como um ecossistema”
(GLIESSMAN, 2000, p. 61). Os agroecossistemas são, então, descritos em termos de como eles se
comparam, estrutural e funcionalmente, como ecossistemas naturais. Segundo Gliessman (2000, p. 61):
Um ecossistema pode ser definido como um sistema funcional de
relações complementares entre organismos vivos e seu ambiente,
delimitados por fronteiras escolhidas arbitrariamente, as quais, no
espaço e no tempo, parecem manter um equilíbrio dinâmico, porem
estável.
Os integrantes do GAU em sua maioria são filhos e filhas de agricultores e agricultoras familiares,
assentados de reforma agrária, indígenas, e trazem vivências das comunidades de formas de organicidade
com um caráter dinâmico e pedagógico que possibilita construir conhecimento que ensina e humaniza. O
mutirão é uma dessas práticas, aderida pelo grupo desde sua formação, sendo inquestionável sua
eficiência como forma de educação libertadora.
Essas atividades coletivas permite pensar a produção de alimentos de base familiar associado com
práticas sustentáveis, fortalecendo o grupo para continuar resistindo na universidade e contrapondo o
modelo convencional de educação, pois a maioria das instituições de ensino pautam como única
possibilidade a agricultura convencional, e na UNEB não é diferente. Portanto a área de produção do GAU
é um espaço de práticas agroecológicas realizadas por meio de discussões e experimentações. Essas
atividades complementam na formação profissional, contribuindo com o fortalecimento da agricultura
camponesa.
2 DESCRIÇÃO DA EXPERIÊNCIA
As atividades foram desenvolvidas com a seguinte metodologia:
Identificar as plantas;
Averiguar os desequilíbrios no agroecossistema;
Dividir as tarefas entre os integrantes.
Foram identificadas plantas nativas, medicinais, alimentícias e espontâneas. Os desequilíbrios
encontrados foram: presença de cochonilha, mosca branca, lagarta, pulgão, formigas e presença de plantas
espontâneas. Logo após houve a formação dos grupos, com três pessoas, cada grupo ficou responsável por
pesquisar a importância econômica, ambiental, política, social e cultural das plantas identificadas na área.
Conhecendo as dificuldades e potencialidades existentes na área os integrantes participaram ativamente
do processo de construção, compreendendo a importância de relacionar os diversos aspectos intrínsecos a
agroecologia. O estudo de uma determinada cultura a partir desta perspectiva permite debater, além do
âmbito agronômico, questões políticas, sócio-ambiental e cultural.](https://image.slidesharecdn.com/topicosemcienciasagrarias-220425113627/85/Topicos-em-ciencias-agrarias-pdf-13-320.jpg)
![Tópicos em Ciências Agrárias – Volume 1
14
Desta forma o GAU planeja quais práticas são necessárias para obter uma produção agroecológica que
contribua na formação humana e profissional dos seus integrantes, assim o mutirão contribui para a teoria
e a prática, o que Freire denomina de práxis, possibilitando aos sujeitos reflexão sobre a ação,
proporcionando uma educação libertadora. “A práxis, porém, é reflexão e ação dos homens sobre o mundo
para transformá-lo. Sem ela, é impossível a superação da contradição opressor-oprimido” (FREIRE, 1987,
p. 38).
Uma característica marcante dessas atividades realizadas por meio de mutirões é a partilha, pois todos
tomam café da manhã juntos, e para isso cada um leva um alimento, símbolo muito forte para a construção
da agroecologia. Logo após ocorre o compartilhamento do conhecimento, onde na prática cada um
contribui para o processo de formação, pois “ninguém educa ninguém, Como tampouco ninguém se educa
a si mesmo: os homens se educam em comunhão, mediatizados pelo mundo” (FREIRE, 1987, p. 79).
Figura 1 – Planejamento das atividades Figura 2 – Troca de saberes Figura 3 – Área Agroecológica
Fonte: Tamara M. Reis Fonte Júlio César N. Santos Fonte: Júlio César N. Santos
3 RESULTADOS
Com o mutirão cada integrante compartilha, além de conhecimentos científicos específico de cada curso,
sua história de vida, seus sonhos, ajudando o grupo a entender melhor cada um, e assim é construído um
laço de comunhão fortalecendo o compromisso com a agroecologia compreendendo a sua
interdisciplinaridade.
Com essa prática há um maior empoderamento dos estudantes membros do GAU, para contrapor na
universidade o modelo convencional de ensino, que nega o conhecimento tradicional, e que discute
agroecologia apenas como nicho de mercado. Para isso fomenta produção de pesquisa junto aos
professores sobre sementes crioulas, formação de agricultores familiares para convivência com o
semiárido, estudo da sustentabilidade dos agroecosistemas familiares e trabalhos com as comunidades
tradicionais.
Contudo, o mutirão é um dos “[...] velhos hábitos solidaristas aplicados a atividades de natureza econômica
e social, hoje em franca decadência, mas obstinadamente ativos nalguns lugares” (CALDEIRA,1956, p. 29).
Portanto é de extrema importância essa prática fomentada no GAU, pois, além de unir o conhecimento
cientifico e saberes tradicionais, mantém viva essa forma de ajuda mútua, não deixando morrer o saber
que a muito tempo vem sendo construído pelas comunidades tradicionais.
AGRADECIMENTOS
Ao Grupo de Agroecologia Umbuzeiro – GAU, por ser um espaço da práxis agroecológica.
REFERÊNCIAS
[1] ANDRADE, Josiele Pantoja de. Labor e prazer: a prática e o sentido dos mutirões na
[2] comunidade Monte Sião, São Domingos do Capim – PA. 2016. 137f. Dissertação (Mestrado em Agriculturas
Familiares e Desenvolvimento Sustentável) - Universidade Federal do Pará, Belém.](https://image.slidesharecdn.com/topicosemcienciasagrarias-220425113627/85/Topicos-em-ciencias-agrarias-pdf-14-320.jpg)
![Tópicos em Ciências Agrárias – Volume 1
15
[3] CALDEIRA, C. Mutirão: formas de ajuda mútua no meio rural. São Paulo, Companhia Editora Nacional,
Brasiliana, 1956.
[4] FREIRE, Paulo. Pedagogia do Oprimido. 17ª ed. Rio de Janeiro: Paz e Terra, 1987.
[5] GLIESSMAN, Stephen R. Agroecologia: processos ecológicos em agricultura sustentável. 1ª ed. Porto Alegre:
Ed, Universidade/UFGS, 2000.](https://image.slidesharecdn.com/topicosemcienciasagrarias-220425113627/85/Topicos-em-ciencias-agrarias-pdf-15-320.jpg)



![Tópicos em Ciências Agrárias – Volume 1
19
produção de tecnologias e de conhecimentos baseados nos princípios da agroecologia e a geração de
renda.
Dos agentes de Ater passou a ser exigido um novo perfil, para que atuem como facilitadores das ações e
serviços de Ater, baseando-se em técnicas que fomentem a participação e o diálogo com o agricultor.
Pretende-se, assim, que haja o distanciamento das práticas tecnicistas e das teorias difusionistas.
4 CONCLUSÃO
A Extensão Rural no Brasil passou por diversas fases de reorganização de suas metas e finalidades,
motivada pela evolução econômica, política, social e cultural e pela necessidade de implementação de
políticas públicas para atender às demandas do meio rural. Inicialmente, os serviços de Ater tiveram
influência direta do sistema capitalista norte-americano e da lógica do capital.
O período da Revolução Verde, apesar de promover avanços na produtividade do campo para abastecer a
indústria, provocou graves problemas de ordem ambiental, social e econômica. A PNATER surge como
resposta aos anseios sociais, trazendo recomendações e uma mudança na forma de orientar o enfoque da
Extensão Rural brasileira, voltando o olhar para as reais necessidades do homem do campo e de sua
família.
A produção agrícola passa ser desenvolvida na perspectiva do uso racional dos recursos, da preservação
ambiental e do desenvolvimento sustentável. Contrapondo-se à orientação produtivista, a nova política
exige a estruturação das entidades de Ater e a adaptação do perfil dos agentes extensionistas. Percebe-se,
no entanto, que ainda vigoram em nosso país práticas tecnicistas, características da Revolução Verde.
A formação do agente extensionista pode ser apontada como um fator que compromete a execução da
PNATER. Para que a PNATER seja plenamente efetivada, os agentes extensionistas devem ter suporte
institucional e se apropriar do conteúdo da política, qualificando a sua prática. As organizações públicas de
extensão rural assumem papel importante neste processo, na medida em que, observando a proposta da
PNATER, passem a disponibilizar recursos e condições aos agentes de extensão rural; monitorem as ações
de Ater e socializem experiências bem sucedidas.
REFERÊNCIAS
[1] BRASIL. Lei nº 12.188, de 11 de janeiro de 2010 – Institui PNATER e o PRONATER, altera a Lei no 8.666, de
21 de junho de 1993, e dá outras providências. Disponível em: <http://www.planalto.gov.br/ccivil_03/_ato2007-
2010/2010/lei/l12188.htm>. Acesso em 26 jun. 2017.
[2] CAPORAL, F. R. A Extensão Rural e os limites à prática dos extensionistas do serviço público. Dissertação
(Mestrado em Extensão Rural) – Universidade Federal de Santa Maria, RS, 1991.
[3] CAPORAL, Francisco Roberto; COSTABEBER, José Antônio. Agroecologia e Desenvolvimento Rural
Sustentável: perspectivas para uma Nova Extensão Rural. 2000. In: CAPORAL, Francisco Roberto; COSTABEBER, José
Antônio.
[4] DIESEL, Vivien; DIAS, Marcelo Miná; NEUMANN, Pedro Selvino. Pnater (2004-2014): da concepção à
materialização. In: GRISA, Catia; SCHNEIDER, Sergio. (Orgs.). Políticas públicas de desenvolvimento rural no Brasil.
Porto Alegre: Editora da UFRGS, 2015. p. 107-128.
[5] JONES. G. E. Prologo. In: TRUJILLO, Fernando Sánchez de Puerta. Extensión agraria y desarrollo rural: Sobre
la evolución de las teorías y praxis extensionistas. Madrid: Ministerio de agricultura, pesca y alimentacion, Secretaria
General Técnica, 1996. 542 p. (Serie Estúdios, nº 123).
[6] Ministério do Desenvolvimento Agrário (MDA). Política Nacional de Assistência Técnica e Extensão Rural.
Versão Final: 25/05/2004. Brasília: 2004.
[7] PAIVA, Mariana Silva de. A política nacional de assistência técnica e extensão rural e os desafios para sua
efetivação no Escritório Local da EMATER em Muriaé – MG. Viçosa, MG, 2012.
[8] PEIXOTO, Marcos. Extensão Rural no Brasil – Uma abordagem histórica da legislação. Série “Textos para
discussão”. Brasília: Consultoria Legislativa do Senado Federal, 2008.](https://image.slidesharecdn.com/topicosemcienciasagrarias-220425113627/85/Topicos-em-ciencias-agrarias-pdf-19-320.jpg)



![Tópicos em Ciências Agrárias – Volume 1
23
4 CONCLUSÃO
O cultivo de macroalgas fez com que a associação crescesse significativamente no âmbito social,
econômico e ambiental, principalmente por ser baseado em princípios de cooperação e solidariedade. Ao
mesmo tempo, mostrou aos maridos as perspectivas futuras para a atividade, além da valorização
enquanto pessoa humana, reduzindo os conflitos familiares.
Observou-se que os pontos relacionados com a gestão da associação são os que merecem mais atenção,
com medidas urgentes a serem tomadas.
REFERÊNCIAS
[1] ASSAD, L. T. e BURSZTYN, M. Aquicultura sustentável. In: Aquicultura no Brasil. Brasília, CNPq/MCT. 2000.
[2] BRASIL. Resultados do recadastramento nacional dos pescadores do Brasil. Brasília/DF, SEAP/PR. 2006.
[3] CAVALCANTI, C. Sustentabilidade da economia: paradigmas alternativos de realização. In:
[4] . Desenvolvimento e natureza: estudos para uma sociedade sustentável. 4ª. Ed. São Paulo: Cortez: Recife:
Fundação Joaquim Nabuco. 2003.
[5] LEFF, E. Racionalidade ambiental: a reaproximação social da natureza. Rio de Janeiro: Civilização Brasileira,
2006.
[6] LEITÃO, M. R. F. A. Gênero e políticas públicas na pesca artesanal de Itapissuma. In: CALLOU, A.
[7] B. F.; TAUK SANTOS, M. S.; GEHLEN, V. R. F. Comunicação, gênero e cultura em comunidades pesqueiras
contemporâneas. Recife/PE: FASA. 2009.
[8] RUAS, E D.; BRANDÃO, I. M. de M.; CARVALHO, M. A. T.; SOARES, M. H. P.; MATIAS, R. F.;
[9] GAVA, R. C.; MESONES, W. G. de La P. Metodologia participativa de extensão rural para o desenvolvimento
sustentável. MEXPAR. Brasília/DF, 2007. 134p.
[10] SANTOS, A. D.; GAMA, A. M. C. de F.; FARIA, A. A. C.; SOUSA, J. A. de.; MELO, L. R. O.;
[11] CHAVES, M. B. F.; FERREIRA NETO, P. S. Metodologias participativas: caminhos para o fortalecimento de
espaços públicos socioambientais. São Paulo: Peirópolis, 2005. 180p.
[12] SANTOS JÚNIOR, J. dos; REBOUÇAS, L. de O.S.; FIGUEIREDO, J.P. do V.; BESSA JÚNIOR,
[13] A.P. SOUZA MAIA, I. Viabilidade econômica de um produto a base de algas da associação de maricultoras do
litoral Norte Potiguar. PUBVET. v.11, n.4, p.313-319, abr., 2017.
[14] SILVA, D.O.; ANJOS, E.G.; SANTANA, J.C.; VELLOSO, T.R. GT02 - As práticas autogestionárias na economia
solidária e no cooperativismo. 2016. (Outro).
[15] SOUZA MAIA, I.; OLIVEIRA-NETO, J.T.; MILLER, F.S. Estudo de viabilidade econômica e gestão democrática de
empreendimento popular: o caso das marisqueiras do semiárido potiguar. UFRN. Natal/RN. 2011.
[16] VALENTI, W.C. Aquicultura sustentável. In: Congresso de zootecnia, 120, Vila Real, Portugal. Associação dos
Engenheiros Zootécnicos. Anais. 2002. p. 111 - 118.
[17] VALENTI, W.C. Aquaculture for sustainable development. In: VALENTI, W.C.; POLI, C.R.; PEREIRA, J.A.;
BORGHETTI, J.R. (Ed.) Aquicultura no Brasil: Bases para um desenvolvimento sustentável. Brasília, CNPq/MCT. 2000.](https://image.slidesharecdn.com/topicosemcienciasagrarias-220425113627/85/Topicos-em-ciencias-agrarias-pdf-23-320.jpg)








![Tópicos em Ciências Agrárias – Volume 1
32
praticantes da agricultura familiar de base agroecológica como um espaço aglutinador das ações dos ditos
agricultores organizados em associações e também dos profissionais comprometidos com este tipo de
ação, e por certo os consumidores interessados na aquisição de produtos saudáveis e frescos.
5 REFLEXÕES FINAIS
Nosso objetivo neste texto foi o de problematizar o atual modelo econômico hegemônico em sua relação
com o campo e as atividades rurais, ligadas a produção, consumo e comercialização de alimentos, e,
também contribuir para visibilizar a existência de algumas iniciativas amazonenses vinculadas a
comercialização de produtos sadios e limpos, procedentes da agricultura orgânica e permacultural e de
outras formas de produção agroecológica. Na verdade, são iniciativas muitas vezes articuladas por setores
existentes dentro da estrutura do estado, e que em certa medida representam atividades pontuais que
certamente demandarão outras estratégias e outros encaminhamentos para que os agricultores de base
agroecológica possam lograr êxito, em assumirem o planejamento, a decisão e execução dos projetos e
atividades de seus interesses.
Por outro lado, como tratamos de tema de grande complexidade, cujo núcleo central de preocupação é o
ser humano, nada melhor que olharmos a presente questão sob a lente de Clifford Geertz (2012), pois,
perceberemos que a cultura é formada por teias de significados tecidas pelo homem. Significados estes
que os homens dão as suas ações e a si mesmos. Assim, pois, o homem do ponto de vista agroecológico
para conhecer a cultura, mas que registrar os fatos deve analisar, interpretar e buscar os significados
contidos nos atos, ritos, performances humanas e não apenas descrevê-lo.
AGRADECIMENTOS
R. Vargas-Isla, agradece ao Centro de Estudos Integrados da Biodiversidade Amazônica (INCT-CENBAM)
pela bolsa de estudos da “Ação Orçamentária – MCTIC/PT 19.571.2021.20VD.0001 (C, T & I para Pesquisa,
Desenvolvimento, Conservação, Valoração e Sustentabilidade dos Recursos Naturais Brasileiros) e à
Coordenação de Aperfeiçoamento de Pessoal de Nível Superior – CAPES pela bolsa do “Programa Nacional
de Pós-Doutorado – PNPD – Processo 88887.357862/2019-00 no Curso de Pós-graduação em
Biotecnologia e Recursos Naturais da Amazônia, UEA.
REFERÊNCIAS
[1] CAPRA, Fritjof. As conexões ocultas: ciência para uma vida sustentável. Trad. Marcelo Brandão Cipolla. São
Paulo: Cultrix. 2008.
[2] CASTELLS, Manuel. A sociedade em redes. São Paulo: Paz e Terra, 2007.
[3] CASTELLS, Manuel. As metamorfoses da questão social. Petrópolis: Vozes. 1999.
[4] CATTANI, Antonio David. Utopia In: A outra economia. Antonio David Cattani (org). Porto Alegre: RS: Veraz
Editores. 2003.
[5] GEERTZ, Clifford. A interpretação das culturas 1ª ed.[reinpr.], Rio de Janeiro: LTC, 2012.
[6] GERVAIS, Ana Maria Dubeux. Região amazônica e economia solidária: uma perspectiva de desenvolvimento
integrado sustentável. In: IDAM, Assistência Técnica e Extensão Rural: construindo o conhecimento agroecológico.
Jorge Roberto Tavares & Ladjane Ramos (orgs), Manaus: 2006. 128p.
[7] INSTITUTO BRASILEIRO DE GEOGRAFIA E ESTATÍSTICA – IBGE, Estimativa populacional das capitais
brasileiras. 2013
[8] KINUPP, Valdely Ferreira, A riqueza alimentar das plantas alimentícias não convencionais-alternativa-
gastronomica-criatividade. Cassandra Castro Manaus, 24 de Agosto de 2013, obtido na internet em
http://acritica.uol.com.br/amazonia/Hortalicas-convencionais-alternativa-gastronomica-
criatividade_0_975502464.html , no dia 18/10/2013
[9] LEMIEUX, Vicent. OUIMET, Mathieu. Análise estrutural das redes sociais. Instituto Piagt, Porto Alegre, 2004.
[10] LISBOA, Armando de Melo. Mercado solidário In: A outra economia. Antonio David Cattani (org) Porto
Alegre: RS: Veraz Editores. 2003.
[11] MALUF, Renato. Produtos Agroalimentares, Agricultura Multifuncional e desenvolvimento territorial no
Brasil. In: Mundo Rural e Cultura. Roberto José Moreira & Luiz Flávio de Carvalho Costa. (orgs) Rio de Janeiro: Mauad.](https://image.slidesharecdn.com/topicosemcienciasagrarias-220425113627/85/Topicos-em-ciencias-agrarias-pdf-32-320.jpg)
![Tópicos em Ciências Agrárias – Volume 1
33
2002.
316p.
[12] MANCE, Euclides André. Redes de colaboração solidária. In: A outra economia. Antonio David Cattani (org)
Porto Alegre: RS: Veraz Editores. 2003.
[13] MARX, Karl. O capital, 5ª Ed. São Paulo. Nova Cultural, 1988. 3v (col. Os economistas).
[14] MOLINA, Manuel González de & TOLEDO, M. Toledo. Metabolismos, naturaleza e historia: hacia una teoría de
las tansformaciones sociológicas. Barcelona/España. Icaria editorial. 2011. 375p. (Colección Perspectivas
Agroecológicas, v.7)
[15] MOURA, Maria Margarida. Camponese. 2ª.ed. São Paulo: Ática. 1988. (Série princípios, v-52)
[16] NAREDO, Mamuel José. 2010. La sumisión de las masas 22/12/2010.
http://blogs.publico.es/delconsejoeditorial/1075/la-sumision-de-las-masas/
[17] NAREDO, Manuel José. 2014. El actual despotismo democrático y sus
alternativashttp://www.rebelion.org/docs/150578.pdf, acessado em 20/08/2014.
[18] SANTOS, Milton. Por uma outra globalização.12. Ed. Rio de Janeiro: Record, 2005.
[19] SANTOS, Milton. Técnica, Espaço, Tempo: globalização e meio técnico-científico-informacional, 5ª. ed. São
Paulo: Edusp. 2008. 176p.
[20] WEBER, Max. Economia e Sociedade. Brasília. UnB. 1994.13-29.](https://image.slidesharecdn.com/topicosemcienciasagrarias-220425113627/85/Topicos-em-ciencias-agrarias-pdf-33-320.jpg)



![Tópicos em Ciências Agrárias – Volume 1
37
conhecimentos. Ao longo destas atividades, o projeto foi monitorado por meio de questionários
avaliativos, mostrando resultados satisfatórios. Nesta etapa, houve participação dos professores da escola.
Em geral, os professores e os monitores buscaram integrar o conhecimento agroecológico a outras
matérias da grade curricular. Atividades como redação, poesia e culinária puderam ser trabalhadas em
conjunto com a professora de Português. Já as operações matemáticas de multiplicação e divisão foram
trabalhadas em uma dinâmica, utilizando hortaliças e sementes. Foram desenvolvidas também atividades
em História e Geografia, sobre a história de Rio Pomba, topografia, povoados nativos e cultura local.
Ocorreu também uma visita técnica ao Instituto Federal de Ciência e Tecnologia do Sudeste de Minas
Gerais, Rio Pomba, no departamento de Agricultura e Ambiente. Esta atividade representou um diferencial
no aprendizado, pois possibilitou aos envolvidos a aproximação da natureza e o discernimento entre o
modo de se produzir de forma sustentável vivenciado na horta, e no horto florestal e pomar do campus do
Instituto. Além disso, ocorreu uma discussão sobre plantio e condução de diferentes espécies florestais da
Mata Atlântica, árvores frutíferas e sua importância em pomares caseiros. Em um momento de
descontração, os alunos realizaram um piquenique sob a sombra da mata, podendo compreender a
importância das árvores para o sombreamento, manutenção da umidade e controle térmico.
Ao final do ano letivo, os pais e familiares dos alunos foram convidados a visitar a escola para participar do
evento de encerramento do projeto. Houve apresentações culturais dos alunos do 3° ano, sob a forma de
obras teatrais sobre conscientização ambiental, e outras atividades lúdicas, como música e dança. No
mesmo evento, ocorreu, em cada sala, uma exposição sobre o tema “Meio Ambiente”, em que se
apresentaram materiais confeccionados ao longo do projeto, que ademais demonstraram como este serviu
de base para a integração entre as disciplinas da grade curricular. Foram abordados diferentes aspectos:
“horta escolar”, “qualidade nutricional de hortaliças e legumes”, “formas de poluição ambiental”,
“confecção de um herbário com plantas nativas da região”, “modo de produção agroecológico e segurança
alimentar”.
AGRADECIMENTOS
Esta atividade foi possível graças à disponibilidade da equipe diretiva e comunidade escolar da Escola
Municipal São José. Também agradecemos ao Instituto Federal de Ciência e Tecnologia, campus Rio
Pomba, pelo apoio técnico, logístico e financeiro.
REFERÊNCIAS
[1] ALTIERI, M. Agroecologia: bases científicas para uma agricultura sustentável. Guaíba: Agropecuária, 2002.
[2] IBGE – Instituto Brasileiro de Geografia e Estatística. Cidades. 2010a. Disponível em:
<http://cidades.ibge.gov.br/xtras/perfil.php?codmun=315580>. Acesso realizado em: 26 de mai. 2015.](https://image.slidesharecdn.com/topicosemcienciasagrarias-220425113627/85/Topicos-em-ciencias-agrarias-pdf-37-320.jpg)




![Tópicos em Ciências Agrárias – Volume 1
42
AGRADECIMENTOS
A Secretaria Especial de Agricultura Familiar e do Desenvolvimento Agrário (SEAD), UNIR e CNPq pela
concessão da bolsa de Extensão no País a primeira autora.
REFERÊNCIAS
[1] Amaral, C. N. do; Neto, G. G. Os quintais como espaços de conservação e cultivo de alimentos: um estudo na
cidade de Rosário Oeste (Mato Grosso, Brasil). Bol. Mus. Para. Emílio Goeldi. Ciências Humanas, Belém, v. 3, n. 3, p.
329-341, set.- dez. 2008.
[2] Aquino, A. M. de; Assis, R. L. Agroecologia: princípios e técnicas para uma agricultura orgânica sustentável –
Brasília, DF : Embrapa Informação Tecnológica, 2005.
[3] EMBRAPA. A importância socioeconômica da batata-doce para a agricultura brasileira. 2015. Disponível em:
< https://www.embrapa.br/busca-de-noticias/-/noticia/7893745/a-importancia-socioeconomica-da-batata-doce-
para-a-agricultura-brasileira >. Acesso em: 24 Mar. 2017.
[4] FAO. Food for the cities. Disponível em: < http://www.fao.org/urban-agriculture/es/>. Acesso em: 24 Mar.
2017.
[5] IBGE. Pesquisa Suplementar de Segurança Alimentar PNAD 2013. Rio de Janeiro, 18 de dezembro 2014.
[6] Machado, A. T.; C. T. T. Machado. Agricultura urbana – Planaltina, DF: Embrapa Cerrados, 2002.
[7] Sonati, J. G.; Affonso, C. V. Pirâmide Alimentar. IN Alimentação saudável e atividade física para a qualidade de
vida. Roberto Vilarta (organizador) - Campinas, IPES Editorial, 2007. 229p.: il.](https://image.slidesharecdn.com/topicosemcienciasagrarias-220425113627/85/Topicos-em-ciencias-agrarias-pdf-42-320.jpg)






![Tópicos em Ciências Agrárias – Volume 1
49
AGRADECIMENTOS
Aos(as) Agricultores(as) Urbanos de Petrolina e a todos que compõem o Núcleos de Segurança Alimentar
e Nutricional - NUSAN Sertão Agroecológico. Ao CNPq pelo apoio a estas ações por meio da Chamada
16/2016 pelo CNPq/MCTIC e Chamada MCTIC/MAPA/MEC/SEAD - Casa Civil/CNPq Nº 21/2016) e à
PROEX/UNIVASF, tendo todos estes contribuído com apoio financeiro e concessão de bolsas.
REFERÊNCIAS
[1] AQUINO, A. M.; ASSIS, R. L. Agricultura orgânica em áreas urbanas e periurbanas com base na
agroecologia.Ambiente & Sociedade. v. 10, n.1. 2007. p. 137-150.
[2] ARRUDA, J. Agricultura urbana na Região Metropolitana do Rio de Janeiro: sustentabilidade e repercussões
na reprodução das famílias. 2011. Tese de Doutorado. Tese (doutorado). Universidade Federal Rural do Rio de Janeiro.
[3] BARROSO, K. A; DIAS, C.B.R; CAPUCHO, A.S; FREITAS, H.R; GONÇALVES-GERVÁSIO, R.de C.R. Diagnóstico de
doenças de plantas em hortas agroecológicas em Petrolina-PE. Extramuros - Edição especial IX
[4] Mostra de Extensão UNIVASF. v. 3, n. 1. 2014. p.146-148.
[5] CASTELO BRANCO M; ALCÂNTARA FA. Hortas urbanas e periurbanas: o que nos diz a literatura brasileira?
Horticultura Brasileira. 29: 421-428. 2011.
[6] FARFÁN, S. J. A. Diagnóstico de hortas comunitárias no dipolo Juazeiro-BA e Petrolina-PE: perfil e demandas
de pesquisas. Juazeiro, 2008. p. 105.
[7] FERREIRA NETO, M. F. Sustentabilidade de Agroecossistemas Periurbanos no Semiárido Nordestino. 2014.
Monografia. (Aperfeiçoamento/Especialização em Metodologias Participativas Aplicadas à Pesquisa, Assistência
Técnica e Extensão Rural) - Fundação Universidade Federal do Vale do São Francisco. 2016. 93p.
[8] MENDONÇA, M. M. de. Semeando Agroecologia nas Cidades. Agriculturas. v. 9, n. 2, setembro de 2012, p. 4-5.
[9] SILVA, S. D. P. Agricultura Urbana e Periurbana: um estudo de caso de duas hortas comunitárias no município
de Petrolina-PE. Trabalho de Conclusão de curso (Graduação em Engenharia Agronômica) – Universidade Federal do
Vale do São Francisco. Campus Ciências Agrárias, Petrolina, 2015. 49p.
[10] SILVA, S.D.P; FREITAS, H.R; GONÇALVES-GERVÁSUIO, R. de C.R; CARVALHO NETO, M.F. de; MARINHO, C.M.
Agricultura Urbana e Periurbana: dinâmica socioprodutivas em hortas comunitárias de Petrolina/PE, Semiárido
Brasileiro. Nucleus, v.15,n.1,abr.2018.
[11] LEITE, I. O. Dinâmicas socioprodutivas e mapeamento de áreas de influência de hortas urbanas de Petrolina:
aspectos sociais, produtivos e distribuição de alimentos nas cidades. Trabalho de conclusão de curso (Graduação em
Ciências Biológicas) – Universidade Federal do Vale do São Francisco. Campus Ciências Agrárias, Petrolina, 2019. 62p.
[12] TRIVIÑOS, A. N. S. Introdução à pesquisa em ciências sociais: pesquisa qualitativa em educação. 1. ed. São
Paulo: Atlas. 1987, 173p.](https://image.slidesharecdn.com/topicosemcienciasagrarias-220425113627/85/Topicos-em-ciencias-agrarias-pdf-49-320.jpg)


![Tópicos em Ciências Agrárias – Volume 1
52
A concentração permanente de pessoas e a ocupação diferenciada do território, em geral desigual e
combinada, escondem relações sociais de poder e exclusão que garantem e reproduzem uma sociedade
desigual, disciplinar e de controle. É a sociedade que se organiza com o advento da Revolução da
Agricultura no momento em que se estabelecem os primeiros assentamentos humanos cuja concentração
humana e de atividades se diferenciavam das rurais, dando início a ordem urbanística (HANNERZ, 2015).
A Revolução Industrial vai inverter as relações de dominação, prevalecendo o predomínio da cidade sobre
o campo (LEFEBVRE, 2001). Atualmente, se fala em Sociedade Pósmoderna – François Lyotard; Sociedade
Pós-Industrial - François Chesnais; Sociedade do Hipertexto – François Ascher; Sociedade Flexível – David
Harvey; Sociedade Líquida – Zygmunt Bauman; Sociedade em Rede – Manuel Castells, Sociedade Pós-
humana – Lúcia Santaella etc. Entre tantas denominações, destacamos a “concepção” de Sociedade Urbana,
desenvolvida por Lefebvre (1999, 2001). Trata-se de uma condição utópica a ser alcançada tendo em vista
o nível de produção e produtividade, de técnica e cultura produzidas no âmbito do capitalismo que torna
possível a superação das vidas precárias dos excluídos, que ainda é uma perspectiva.
A sociedade urbana utópica de Lefebvre supera as dicotomias hegemônicas, construídas pelo senso
comum e pelo pensamento intelectual. Partindo do entendimento da sociedade industrial, para ele o
direito à cidade nasce da contradição existente entre as realidades da sociedade atual – segregação e
exclusão generalizadas e os fatos de civilização que nela se inscrevem. Nessa perspectiva, o individual se
afirma pelas resistências das massas. Assim, o direito à cidade, segundo Lefebvre, são conquistas sociais
na direção de uma sociedade urbana que supera os valores de troca pelos valores de uso na vida coletiva.
Por outro lado, Touraine (2011) esclarece que na atualidade a resistência das massas não pode se basear
no sujeito individual pela impossibilidade de sua existência. A pluralidade e diversidade cultural
contemporânea reúnem grupos e tribos de diversas etnias, raças, religiosidades, sexos, gênero etc. A
resistência, portanto, para esse sociólogo se baseia na diferença social e no reconhecimento dos diferentes.
Os direitos à cidade passam a ser direitos culturais que se apresentam como resistência política. Assim,
com esses entendimentos, podemos admitir que na atualidade o entendimento do “desenvolvimento”
rural se desloca para a construção de territórios culturais de resiliência, resistência e enfrentamento da
exclusão social e da pobreza, na luta pela conquista de direitos à cidade, entendidos como direitos
culturais, seja no campo ou na cidade.
Nesse sentido, a partir das pistas levantadas na discussão dos artigos escritos por Endlich; Bernardelli;
Rosa e Ferreira; Sobarzo; Sposito; Saquet sobre cidade e campo; tendo como princípio a sociedade urbana,
proposta por Henry Lefebvre e baseadas no ativismo cultural, proposto por Alain Touraine, verifica-se a
necessidade de construção de novas territorialidades, compreendidas como campos de poder e ação,
delimitadas por forças de resiliência e resistência política da população excluída e pobre. É a possibilidade
de formulação de um desenvolvimento urbano que não separa o campo da cidade, enfrentando a ordem
capitalista que o divide.
REFERÊNCIAS
[1] TORAINE, Alain. Após à crise; a decomposição da vida social e o surgimento de atores sociais. Tradução de
Francisco Morás. – Petrópolis, RJ, Vozes, 2011.
[2] BERNADELLLI, Maria Lúcia Falconi da Hora. Contribuição ao debate sobre o urbano e rural.
[3] In SPOSITO, Maria Encarnação Beltrão,
[4] WHITACKER, Arthur Aagnon (Orgs.). Cidade e campo e contradições sobre o urbano e rural. 3ª ed. – São
Paulo: Outras Expressões, 2013.
[5] ENDLICH, Maria Ângela. Perspectivas sobre o urbano e rural. In SPOSITO, Maria Encarnação Beltrão,
[6] WHITACKER, Arthur Aagnon (Orgs.). Cidade e campo e contradições sobre o urbano e rural. 3ª ed. – São
Paulo: Outras Expressões, 2013.
[7] LEFEBVRE, Henri. O direito à cidade. Tradução de Rubens Eduardo Farias. – São Paulo: Centauro, 2001.
[8] HANNERZ, Ulf. Explorando a cidade: em busca de uma antropologia urbana. Tradução de Vera Joselyne. –
Petrópolis, RJ: Vozes, 2015.
[9] HERZFELD, Michael. Pratica teórica na cultura e na sociedade. Tradução de Nóeli Correia de Melo Sobrinho. –
Petrópolis, RJ: Vozes, 2014. ____. A revolução urbana. Tradução de Sérgio Martins. – Belo Horizonte: Ed. UFMG, 1999.
SOBARZO, Oscar. O urbano e o rural em Henri Lefebvre. In SPOSITO, Maria Encarnação Beltrão,
[10] WHITACKER, Arthur Aagnon (Orgs.). Cidade e campo e contradições sobre o urbano e rural. 3ª ed. – São
Paulo: Outras Expressões, 2013. ROSA, Lucelina Rosseti,](https://image.slidesharecdn.com/topicosemcienciasagrarias-220425113627/85/Topicos-em-ciencias-agrarias-pdf-52-320.jpg)
![Tópicos em Ciências Agrárias – Volume 1
53
[11] FERREIRA, Darlene Aparecida de Oliveira. As categorias rural, urbano, campo, cidade: a perspectiva de um
continuum. In SPOSITO, Maria Encarnação Beltrão, WHITACKER, Arthur Aagnon (Orgs.). Cidade e campo e
contradições sobre o urbano e rural. 3ª ed. – São Paulo: Outras Expressões, 2013.
[12] SAQUET, Marcos Aurélio. Por uma abordagem territorial das realções urbano-rurais no Sudeste paranaense.
In SPOSITO, Maria Encarnação Beltrão, WHITACKER, Arthur Aagnon (Orgs.). Cidade e campo e contradições sobre o
urbano e rural. 3ª ed. – São Paulo: Outras Expressões, 2013. SPOSITO, Maria Encarnação Beltrão. A questão cidade e
campo: perspectiva a partir da cidade.
[13] In ____, WHITACKER, Arthur Aagnon (Orgs.). Cidade e campo e contradições sobre o urbano e rural. 3ª ed. –
São Paulo: Outras Expressões, 2013.](https://image.slidesharecdn.com/topicosemcienciasagrarias-220425113627/85/Topicos-em-ciencias-agrarias-pdf-53-320.jpg)




![Tópicos em Ciências Agrárias – Volume 1
58
AGRADECIMENTOS
Agradecemos ao Sebrae por disponibilizar e permitir a análise dos dados do Projeto ADRS Bioma Caatinga
REFERÊNCIAS
[1] GRISA, C., WESZ JUNIOR, V. J., BUCHWEITZ, V. D. Revisitando o Pronaf:
velhos questionamentos, novas interpretações. RESR, Piracicaba-SP, Vol. 52, Nº 02, p. 323-346, Abr/Jun 2014.
[2] HOLANDA JUNIOR, E. V., OLIVEIRA, C. A. V. Fatores de Diferenciação dos Produtores de Caprinos e Ovinos do
Sertão Baiano do Vale do São Francisco. Separatas, Embrapa Caprinos e Ovinos. 2005.
[3] SENAI - Serviço Nacional de Aprendizagem Industrial. Estudo da viabilidade técnica e econômica para o
desenvolvimento da caprinocultura no Nordeste. Brasília, DF, 2007. 142 p.
[4] IBGE - FUNDAÇÃO INSTITUTO BRASILEIRO DE GEOGRAFIA E ESTATÍSTICAS - Sistema IBGE de Recuperação
Automática. Pesquisa Pecuária Municipal, 2015. Disponível em: http://www.sidra.ibge.gov.br/. Acesso em:
12/10/2017.](https://image.slidesharecdn.com/topicosemcienciasagrarias-220425113627/85/Topicos-em-ciencias-agrarias-pdf-58-320.jpg)




![Tópicos em Ciências Agrárias – Volume 1
63
REFERÊNCIAS
[1] CARLOTTO, I.; FILIPPI, J. A.; MARCELLO, I. E. Estudo da viabilidade da produção de leite em uma propriedade
familiar rural do município de Francisco Beltrão – PR. Rev. Ciênc. Empres. UNIPAR, Umuarama, v. 12, n. 1, p. 95-109,
jan./jun. 2011.
[2] COMPANHIA NACIONAL DE ABASTECIMENTO. Custos de produção agrícola: a metodologia da Conab.
Brasília, 2010.
[3] HOFER, E; et al. A Relevância do Controle Contábil para o Desenvolvimento do Agronegócio em Pequenas e
Médias Propriedades Rurais. Revista de Contabilidade e Controladoria, ISSN 1984-6266 Universidade Federal do
Paraná, Curitiba, v. 3, n.1, p.27-42, jan./abr. 2011.
[4] NACHILUK, K.; OLIVEIRA, M. D. M. Custo de Produção: uma importante ferramenta gerencial na
agropecuária. Análises e Indicadores do Agronegócio, v. 7, n. 5, maio 2012.
[5] MATTOS, J. G. Sistema de apropriação de custos do hospital universitário da UFSC, um diagnóstico da
situação atual. Monografia - Curso de Especialização em Gestão Hospitalar, UFSC, Florianopolis, 1998.](https://image.slidesharecdn.com/topicosemcienciasagrarias-220425113627/85/Topicos-em-ciencias-agrarias-pdf-63-320.jpg)






![Tópicos em Ciências Agrárias – Volume 1
70
(g)
A confecção dos mapas de krigagem mostraram ser uma ferramenta relevante para o conhecimento da
dinâmica espacial da resistência do solo a penetração e dos atributos químicos do solo na área de
eucalipto, fornecendo informações importantes quanto ao planejamento e manejo da área, podendo ser
utilizada na tomada de decisão, para a conservação e manutenção da qualidade dos solos agrícolas.
4. CONCLUSÕES
Os valores médios para a altura do eucalipto (3,24 m) e diâmetro à altura do peito (2,37 cm) foram
considerados satisfatórios quando comparados com o cultivo de eucalipto em solos argilosos
apresentando alta variabilidade.
A resistência mecânica do solo (0,99 e 3,20 MPa) apresentou baixa compactação devido a desagregação do
solo para a implantação do eucalipto não limitando assim o crescimento inicial do eucalipto.
Os atributos químicos do solo (fósforo, matéria orgânica, cálcio e manésio) apesar de apresentarem baixos
teores, são suficientes para o desenvolvimento do eucalipto por serem uma espécie pouco exigente em
nutrientes, quando comparados à maioria das culturas agrícolas. Por outro lado, apresentou altos teores
de alumínio (8,67 e 9,93 mmolc dm-3) e baixo pH (4,28 e 4,06) que também não são limitantes ao
eucalipto por ser uma espécie melhorada geneticamente para se desenvolver nesses ambientes alcalinos.
Os mapas de isolinhas confeccionados permitiram visualizar a distribuição dos elementos químicos
estudados e a influência nos parâmetros de crescimento do eucalipto cultivado em solo arenoso, se
tornando uma importante ferramenta para o planejamento da produção dessas áreas.
REFERÊNCIAS
[1] AFZAL, S.; NAWAZ, M.F.; SIDDIQUI, M.T.; ASLAM, Z. Comparative study on water use efficiency between
introduced species (Eucalyptus camaldulensis) and indigenous species (Tamarix aphylla) on marginal sandy lands of
Noorpur Thal. Pakistan Journal of Agricultural Sciences, v.55, n.1, p.127-135, 2018.
[2] ALVARES, C.A.; STAPE, J.L.; SENTELHAS, P.C.; GONÇALVES, J.L.; MORAES, G.; SPAROVEK. G. Köppen’s climate
classification map for Brazil. Meteorologische Zeitschrift, v.22, n.6, p.711-728, 2013.
[3] AQUINO, R.E; CAMPOS, M.C.; MARQUES JÚNIOR, J.; IVANILDO, A.O.; MANTOVANELI, C.B.; SOARES, M.D.R.
Geoestatística na avaliação dos atributos físicos em Latossolo sob floresta nativa e pastagem na região de Manicoré,
Amazonas. Revista Brasileira de Ciência do Solo, v.38, n.2, p.397-406, 2014.
[4] BARTIERES, E.M.M.; CARNEVALI, N.H.S.; LIMA, E.S.; CARNEVALI, T.O.; MALLMANN, V. Hidrogel, calagem e
adubação no desenvolvimento inicial, sobrevivência e composição nutricional de plantas híbridas de eucalipto.
Pesquisa Florestal Brasileira, v.36, n.86, p.145-151, 2016.
[5] CORÁ, J.E.; ARAUJO, A.V.; PEREIRA, G.T.; BERALDO, J. M. G. Variabilidade espacial de atributos do solo para
adoção do sistema de agricultura de precisão na cultura de cana-de-açúcar. Revista Brasileira de Ciência do Solo, v.25,
n.6, p.1013-1021, 2004.
[6] DALCHIAVON, F.C.; CARVALHO, M.P.; MONTANARI, R.; ANDREOTTI, M.; PANOSSO, A.R. Produtividade da
cana-de-açúcar: Variabilidade linear e espacial entre componentes tecnológicos e da produção. Bioscience Journal, v.
30, n. 1, p. 390-400, 2014.](https://image.slidesharecdn.com/topicosemcienciasagrarias-220425113627/85/Topicos-em-ciencias-agrarias-pdf-70-320.jpg)
![Tópicos em Ciências Agrárias – Volume 1
71
[7] GAMMA DESIGN SOFTWARE GS+: Geostatistics for environmental sciences. 7.ed. Michigan, Plainwell:
Gamma Design Software, 159p. 2004.
[8] PIMENTEL-GOMES, F.P.; GARCIA, C.H. Estatística aplicada a experimentos agronômicos e florestais.
Piracicaba: FEALQ, 309p. 2002.
[9] R CORE TEAM. R: A language and environment for statistical computing. R Foundation for Statistical
Computing, Vienna, Austria, 2017.
[10] RAIJ, B.V.; ANDRADE, J.C.; CANTARELLA, H.; QUAGGIO, J.A. Análise química para avaliação da fertilidade de
solos tropicais. Campinas: Instituto Agronômico, 285p. 2001.
[11] REIS, V.R.R.; DEON, D.S.; MUNIZ, L.C.; GARCIA, U.S.; CANTANHÊDE, I.S.L.; REGO, C.A.R.M.; COSTA, J.B.;
MARQUES, E.O. Soil chemical attributes under crop-livestock-forest integration system and in different land uses in
Mata dos Cocais Region. Journal of Agricultural Science, v.10, n.4, p.370-380, 2018.
[12] RESENDE, J.M.A.; MARQUES JÚNIOR, J.; MARTINS FILHO, M.V.; DANTAS, J.S.; SIQUEIRA, D.S.; TEIXEIRA, D.B.
Variabilidade espacial de atributos de solos coesos do leste maranhense. Revista Brasileira de Ciência do Solo, v. 38, n.
1, p. 1077-1090, 2014.
[13] RODRIGUES, F.A.V.; ALVAREZ, V.V.H.; BARROS, N.F.; SILVA, I.R.; NEVES, J.C.L. Produtividade de eucalipto aos
18 meses de idade, na região do Cerrado, em resposta à aplicação de cálcio, via calcário e gesso agrícola. Scientia
Forestalis, v.44, n.109, p.67-74, 2016.
[14] SANTOS, H.G.; JACOMINE, P.K.T.; ANJOS, L.H.C.; OLIVEIRA, V.A.; LUMBRERAS, J.F.; COELHO, M.R.; ALMEIDA,
J.A.; ARAUJO FILHO, J.C.; OLIVEIRA, J.B.; CUNHA, T.J.F. Sistema Brasileiro de Classificação de Solos. 5ª Ed. Revista e
Ampliada, Brasília: Embrapa, 353p. 2018.
[15] SCOLFORO, H.F.; MCTAGUE, J.P.; BURKHART, H.; ROISE, J.; CAMPOE, O.; STAPE, J.L. Eucalyptus growth and
yield system: Linking individual-tree and stand-level growth models in clonal Eucalypt plantations in Brazil. Forest
Ecology and Management, v.432, p.1-16, 2019.
[16] SILVA NETO, S.P.; SANTOS, A.C.; SILVA, J.E.C. Variabilidade espacial da fertilidade de Neossolo Quartzarênico
em função da substituição do cerrado por pastagem. Engenharia na Agricultura, v.19, n.4, p.334-347, 2011.
[17] SILVEIRA, R.L.V.A.; HIGASHI, E.N.; SGARBI, F.; MINIZ, M.R.A. Seja o doutor do seu eucalipto. POTAFOS -
Informações Agronômicas n.93, 32p. 2001.
[18] SOIL TAXONOMY. Keys to Soil Taxonomy. 12th ed. Washington: USDA-Natural Resources Conservation
Service, 2014.
[19] STOLF, R.; MURAKAMI, J.H.; BRUGNARO, C.; SILVA, L.G.; SILVA, L.C.F.; MARGARIDO, L.A.C. Penetrômetro de
impacto Stolf - programa computacional de dados em EXCEL-VBA. Revista Brasileira de Ciência do Solo, v.38, n.3,
p.774-782, 2014.
[20] WRB FAO. World reference base for soil resources 2014. International soil classification system for naming
soils and creating legends for soil maps. Rome: World Soil Resources Reports, 2015.](https://image.slidesharecdn.com/topicosemcienciasagrarias-220425113627/85/Topicos-em-ciencias-agrarias-pdf-71-320.jpg)



![Tópicos em Ciências Agrárias – Volume 1
75
Segundo Borém e Ramos (2002), os nutrientes contidos na serrapilheira estão mais protegidos contra
lixiviação que os armazenados no solo porque, na sua maioria, fazem parte de compostos orgânicos.
O clima quente e úmido da região ocasiona uma decomposição muito rápida do Material vegetal
(serrapilheira) presente no solo, devido principalmente às altas temperaturas a que estão submetidos e ao
auxílio do intemperismo. Consequentemente, o Material decomposto é disponibilizado aos vegetais,
auxiliando assim na manutenção do ecossistema que tem sua necessidade de nutrientes rapidamente
supridas com a ciclagem dos nutrientes, compensando a pobreza do solo (LUIZÃO, 1982). Além disso, a
matéria orgânica depositada sobre o solo diminui a erosão minimizando o impacto das gotas de chuva,
aumenta a taxa de infiltração e retenção da água sendo, portanto, a vegetação é fundamental para a
manutenção ou retomada dos processos ecológicos.
4 CONCLUSÕES
A palha de babaçu é um insumo promissor para o controle da vegetação espontânea. A dosagem simples
de 8,3 Mg ha-1 não apresentou grande redução para as monocotiledôneas, porém a dosagem dupla inibiu
os pteridófitos e reduziu as monocotiledôneas da vegetação espontânea. A concentração de nitrogênio, foi
elevada na área com densidade de 50% das palmeiras, tornando-se a densidade ideal para disponibilidade
do nutriente ao solo. Dado a natureza ubiquitária e de zero-custo, a palha de babaçu parece ser um insumo
alternativo promissor que pode ser utilizada como estratégia de controle de plantas espontâneas e
contribuição nutricional em áreas de agricultura familiar de subsistência no Maranhão.
REFERÊNCIAS
[1] AGUIAR, A. C. F.; BICUDO, S. J.; COSTA SOBRINHO, J. R. S.; MARTINS, A. L. S.; COELHO, K. P.; MOURA, E. G.
Nutrient recycling and physical indicators of an alley cropping system in a sandy loam soil in the pre-Amazon region
of Brazil. Nutrient Cycling in Agroecosystems, v. 86, n. 2, p. 189-198, 2010/03/01 2010.
[2] BALICK, M. J.; PINHEIRO, C. U. B.. Babassu. em: Clay, J. W.; CLEMENT, C. R. Selected species and strategies to
enhance income generation from Amazonian forests.
[3] FAO, Roma. p 177-188, 2000.
[4] BORÉM, R.A.T.; RAMOS, D.P. Variaçao estacional e topografica de nutrientes na serrapilheira de um
fragmento da Mata Atlântica. Revista Cerne, Lavras, v. 8, n. 2, p. 4259. 2002.
[5] LUIZÃO, F. J. Produção e decomposição de liteira em floresta de terra firme da Amazônia Central: Aspectos
químicos e biológicos da lixiviação e remoção de nutrientes da liteira. 1982. 107 f. Dissertação (Mestrado) - INPA/FUA,
Manaus, 1982.](https://image.slidesharecdn.com/topicosemcienciasagrarias-220425113627/85/Topicos-em-ciencias-agrarias-pdf-75-320.jpg)

![Tópicos em Ciências Agrárias – Volume 1
77
1] INTRODUÇÃO
O Brasil é um dos principais países produtores de frutas, ocupando o terceiro lugar, depois da China e
Estados Unidos, com uma produção média de 40 milhões de toneladas (PAM, 2016) e essa produção tende
a crescer, devido ao aumento do consumo pela população que está em busca de uma alimentação mais
saudável.
O clima tropical do país e a grande extensão territorial, nos beneficia com a produção de grande variedade
de frutas, desde os de clima tropical a temperados. As principais frutas produzidas segundo a FAO são
laranja, banana, abacaxi, melancia e mamão.
Porém este potencial produtivo tem sido afetado pelo que se chama perdas pós-colheita. Segundo Chitarra
e Chitarra (2005) a falta de tecnificação da cadeia produtiva, não só no Brasil, mas em todos países em
desenvolvimento, onde o manejo, armazenamento e transporte após a colheita não são adequados, e as
más condições das estradas favorecem aos danos físicos, que são a porta de entrada das doenças que
levam a deterioração dos frutos, gerando perdas de até 40% na produção de bananas e tomate e 30% de
mamão.
Dentre os fatores bióticos responsáveis pelas perdas, os fungos são os principais fitopatógenos que afetam
a produção de frutas, chegando a causar até 80% das doenças, sendo favorecidas infecções devidas o pH
das frutas serem abaixo de 4,5 estando na faixa de preferência para a colonização por fungos (PARISE,
2015).
O Fusarium sp. e muitos outros fungos fitopatogênicos, são descritos como fungos causadores de podridão
de frutos, doença que causa o amolecimento, escurecimento, mudança no sabor e odor da região infectada.
Os fungos produzem enzimas que promovem a desintegração celular no tecido dos frutos, afetando
diretamente o protoplasto. O Fusarium sp. é um dos principais fungos causadores de doenças pós-colheita,
provocando podridão de talo, e rachaduras no fruto (Embrapa, 2008).
O controle químico é o mais utilizado atualmente no controle das doenças, entretanto, esses produtos
possuem elevada toxicidade e a sociedade está cada vez mais preocupada com os problemas relacionados
ao uso continuo e intensivo de agroquímicos, por todos os possíveis danos ao ser humano e ao meio
ambiente. Desta forma, intensifica-se a busca por alternativas que sejam eficientes, viáveis e que causem
menor impacto ambiental e riscos à saúde humana (DANTAS, 2003), como a utilização de óleos essenciais
extraídos de plantas no controle desses fungos fitopatogênicos.
Esses óleos essenciais são compostos complexos que apresentam valor toxicológico, inúmeras funções no
organismo vegetal e apresentam diversas atividades biológicas, assim sendo, podem ter aplicações nas
mais distintas áreas econômicas, como no controle de pragas e doenças agrícolas. (SALGADO et al, 2003).
Dentre as famílias vegetais têm espécies detentoras de óleos essenciais. Algumas foram extensivamente
estudadas quanto a sua composição química e atividades biológicas, no entanto mediante o contexto
exposto anteriormente ainda se faz necessário estudos aprofundados.
A família Lamiaceae compreende mais de 200 gêneros e algo entre 2000 e 5000 espécies e está inserida no
gênero Mentha, foi demonstrado que a biossíntese de óleos essenciais ocorre especificamente nos
tricomas glandulares peltados, distribuídos ao longo da superfície foliar (GERSHENZON et al., 1989;
MCCASKILL et al., 1992). A Menta possui uma significativa produção de óleos essenciais, mas a sua
compreensão ainda carece de elucidação, pois ainda não foi totalmente alcançada. Seu híbrido é conhecido
como M. x piperita e é amplamente utilizado na indústria alimentícia em função de seus componentes
majoritários, o mentol e a mentona (GUL, 1994). Estes geralmente são tidos como modelo nos estudos do
metabolismo de monoterpenos no gênero (AFLATUNI, 2005). Apesar da importância desses constituintes,
nem todas espécies os tem como constituição principal podendo apresentar diferentes propriedades
biológicas.
Uma das espécies inseridas a este gênero, a Mentha arvensis é dotada de grandes potencialidades
biológicas, entre as quais destaca-se a ação fungitóxica Peixinho, Ribeiro e Amorim (2016) demonstrada
na avaliação da inibição do crescimento micelial de L. theobromae, sendo que, no trabalho em questão, o
óleo essencial de M. arvensis foi capaz de inibir em 100% o crescimento micelial em todas as
concentrações testadas.
Outra família amplamente explorada quanto a sua importância como fonte de óleos essenciais é a família
Myrtaceae, com algo em torno de 130 gêneros e 2900 espécies, distribuídas em praticamente todas as
regiões tropicais e subtropicais do globo (VESGA et al, 2014). O gênero Eucalyptus, composto por mais de](https://image.slidesharecdn.com/topicosemcienciasagrarias-220425113627/85/Topicos-em-ciencias-agrarias-pdf-77-320.jpg)

![Tópicos em Ciências Agrárias – Volume 1
82
REFERÊNCIAS
[1] AFLATUNI, A. The yield and essential oil content of mint (Mentha ssp.) in Northern Ostrobothnia (2005). 50 f.
2005. Dissertation (Master) - University of Oulu, Finland, 2005.
[2] ALFENAS, A.C.; FERREIRA, F.A.; MAFIA, R.G.; GONÇALVES, R.C. Isolamento de Fungos fitopatogênicos. In:
ALFENAS, A. C.; MAFIA, R. G. (Eds) Métodos em Fitopatologia. Viçosa, MG: UFV, p 53-90, 2007.
[3] BONALDO, S.M. Atividade Elicitora de Fitoalexinas e Proteção de Pepino contra Colletotrichum lagenarium,
pelo Extrato Aquoso de Eucalyptus citriodora*. ESALQ/USP: Fitopatologia Brasileira, 2004. Disponível em:
http://Fungitoxicidade, Atividade Elicitora de Fitoalexinas e Proteção de Pepino contra Colletotrichum lagenarium,
pelo Extrato Aquoso de Eucalyptus citriodora*. Acesso em: 05 jul. 2018.
[4] CHITARRA, M.I.; CHITARRA, A. Pós-colheita de frutas e hortaliças: fisiologia e manuseio. 2. ed. Lavras/MG:
UFLA, 2005. 785 p. Disponível em: http://file:///E:/
User/Downloads/LIVRO%20POS%20COLHEITA%20FRUTAS%20E%20HORTALI%C3%87AS.PDF. Acesso em: 15 jun.
2018.
[5] DANTAS, S. Doenças Fúngicas Pós-Colheita em Mamões e Laranjas Comercializados na Central de
Abastecimento do Recife. Universidade Federal Rural de Pernambuco, DEPA-Fitossanidade: Fitopatologia Brasileira,
2003. Disponível em: http://www.scielo.br/pdf/fb/v28n5/17667.pdf. Acesso em: 12 out. 2018.
[6] Estratégias de controle de podridões em pós-colheita de melão: uma Revisão. Fortaleza/CE: EMBRAPA
AGROINDÚSTRIA TROPICAL, 2008. Disponível em:
http://www.cpatsa.embrapa.br/public_eletronica/downloads/OPB1947.pdf. Acesso em: 21 jul. 2018.
[7] GERSHENZON, J.; MAFFEI, M.; CROTEAU, R. Biochemical and histochemical localization of monoterpene
biosynthesis in the glandular trichomes of spearMint. Plant Physiology, Rockville, v. 89, n. 4, p. 1351 - 1357, 1989.
[8] GUL, P. Seasonal variation of oil and menthol content in Mentha arvensis Linn. Pakistan Journal of Forestry,
Peshawar, v. 44, n. 1, p. 16-20, 1994.
[9] McCASKILL, D.; GERSHENZON, J.; CROTEAU, R. Morphology and monoterpene biosynthetic capabilities of
secretory cell clusters isolated from glandular trichomes of pepper Mint. Planta, Berlin, v. 187, n. 4, p. 445-454, 1992.
[10] PAM 2016: Valor da produção agrícola nacional foi 20% maior do que em 2015. 2017. Disponível em:
https://agenciadenoticias.ibge.gov.br/agencia-sala-de-imprensa /2013-agencia-de-noticias/releases/16814-pam-
2016-valor-da-producao-agricola-nac ional-foi-20-maior-do-que-em-2015. Acesso em: 28 jun. 2018.
[11] PARISI, M.; HENRIQUE, C.M.; PATRI, P. Doenças pós-colheita: um entrave na comercialização. 12. 2015.
Disponível em: <http://www.aptaregional.sp .gov.br/acesse-os-artigos-pesquisaetecnologia/edicao-2015/julho-
dezembro-3/1 667-doencaspos-colheita-um-entrave-na-comercializacao/file.html>. Acesso em: 07 jun. 2018.
[12] SALGADO, A. P. S. P.; CARDOSO, M.G.; SOUZA, P. E.; SOUZA, J. A.; ABREU, C. M. P.; PINTO, J. E. B. P. Avaliação da
atividade fungitóxica de óleos essenciais de folhas de Eucalyptus SOBRE Fusarium oxysporum, Botrytis cinerea E
Bipolaris sorokiniana. Ciênc. agrotec., Lavras, v.27, n. 2, p. 249 - 254, mar./abr., 2003.
[13] PEIXINHO, G. S.; RIBEIRO, V. G.; AMORIM, E. P. R. Ação do óleo essencial de menta (Mentha arvensis) sobre o
patógeno Lasiodiplodia theobromae em cachos de videira cv. Itália. Summa Phytopathol., Botucatu, v. 43, n. 1, p. 32 -
35, 2017.
[14] VESGA, L. C.; BUENO, Y.; STASHENKO, E. E.; MENDEZ-SANCHEZ, S. C. Efeito do óleo essencial de Eucalyptus
citriodora sobre o metabolismo energético mitocondrial. Rev. Colomb. Quim., v. 43, n. 2, p. 10 – 17, 2014.](https://image.slidesharecdn.com/topicosemcienciasagrarias-220425113627/85/Topicos-em-ciencias-agrarias-pdf-82-320.jpg)



![Tópicos em Ciências Agrárias – Volume 1
86
REFERÊNCIAS
[1] PRIMAVESI, Ana. O solo tropical - Casos Perguntando sobre solo. – São Paulo: Movimento Dos Trabalhadores
Rurais Sem Terra – MST, 1ª edição, 2009. P. 116.
[2] SEVERINO, F. J. A teoria da trofobiose. PG - DR – Fitotecnia. - Piracicaba – SP, 2001.
[3] CHABOUSSOU, Francis. Plantas doentes pelo uso de agrotóxicos: a teoria da trofobiose. Tradução de
GUAZELLI, M. J. - Porto Alegre: L&PM, 1987. 256p.](https://image.slidesharecdn.com/topicosemcienciasagrarias-220425113627/85/Topicos-em-ciencias-agrarias-pdf-86-320.jpg)



![Tópicos em Ciências Agrárias – Volume 1
90
natural por áreas agrícolas influenciou no baixo valor dos cátions, corroborando a justificativa da grande
disponibilidade de íons Al3+ no presente estudo.
Nos cultivos de mandioca (0,5 cmolc/dm3) e pimenta do reino (0,8 cmolc/dm3) teores de Al+3
apresentaram concentrações na faixa de (0,3 – 1,0 cmolc/dm3), considerada média, segundo a classe de
interpretação de Brasil e Cravo (2007). Sobral et al. (2015), afirma que algumas culturas são prejudicadas
por não desenvolver sistema radicular devido teores de Al+3 acima de (0,5 cmol/dm3) inibindo a presença
de nutrientes essências para tal cultura. Contudo estudos mostram que o valor adequado para um bom
desenvolvimento das culturas deve ser menor que (0,5 cmol/dm3).
Os valores de SB em lavouras de mandioca tiveram média de (1,1 cmolc/dm3) e pimenta do reino (0,6
cmolc/dm3), índices considerados baixos (1,81- 3,6), conforme Prezotti e Martins (2013). Leite et al.
(2010), devido fatores como o manejo inadequada do solo com a junção de processos de lixiviação
resultam nos valores da presente pesquisa.
A CTC efetiva nos cultivos de mandioca e pimenta do reino obtiveram média de (1,7 cmolc/dm3), valores
considerados baixos (< 2,5 cmolc/dm3), segundo Prezotti e Martins (2013). Ronquim (2010), afirma que a
CTC efetiva baixa é justificada pela menor capacidade do solo em disponibilizar cátions na forma trocável.
4 CONCLUSÃO
Os resultados obtidos das propriedades químicas apresentaram valores semelhantes nos cultivos de
mandioca e pimenta do reino, evidenciando o empobrecimento dos nutrientes P, K+, Ca2+ e Mg2+, Al3+,
SB e CTC efetiva no solo, ocorrência está pela falta de manejos e práticas agrícolas, por partes dos
produtores, resultando na diminuição destes nutrientes durante os períodos de plantio.
REFERÊNCIAS
[1] ARRUDA, M. R; MOREIRA, A.; PEREIRA, J. C. R. Amostragem e Cuidados na Coleta de Solo para Fins de
Fertilidade. Manaus: Embrapa Amazônia Ocidental, 2014. 18p.
[2] BALOTA, E. L; KANASHIRO, M; COLOZZI FILHO, A; ANDRADE, D. S; DICK, R. P. Soil enzyme activities under
long-term tillage and crop rotation systems in subtropical agro-ecosystems.
[3] BERNARDI, A. C. C; MACHADO, P. L. O. A; SILVA, C. A. Fertilidade do solo e demanda por nutrientes no Brasil.
In: MANZATTO, C. M; FREITAS JÚNIOR, E; PERES, J. R. R. Uso agrícola dos solos brasileiros. Rio de Janeiro: Embrapa
Solos. 2002. p. 61-77.
[4] BRASIL, E. C.; CRAVO, M. da S. Interpretação dos Resultados de Análise de Solo. In: CRAVO, M. S.; VIÉGAS, I. J.
M.; BRASIL, E.C. (Org.). Recomendações de Adubação e Calagem para o Estado do Pará. 1. ed. Belém: Embrapa
Amazônia Oriental, 2007, p. 42-48.
[5] BROGGI, F; FREIRE, F. J; FREIRE, M. B. G. S; NASCIMENTO, C. W. A; OLIVEIRA, A. C. Avaliação da
disponibilidade, absorção e níveis críticos de fósforo em diferentes solos. Revista Ceres, Viçosa, v. 57, n. 2, p. 247-252,
2010.
[6] CONTO, A. J; HOMMA, A. K. O; GALVÃO, E. U. P; FERREIRA, C. A. P; AMORIM, R. A. A. Modernização da pequena
propriedade na região Nordeste do Estado do Pará. In: CONGRESSO BRASILEIRO DE ECONOMIA E SOCIOLOGIA
RURAL, 34, 1996, Aracaju. Anais... Brasília: SOBER, 1996. p. 385-410.
[7] EMBRAPA AMAZÔNIA ORIENTAL. Recomendações de adubação e calagem para o estado do Pará. Belém, PA,
p. 19-130, 2007.
[8] EMPRESA BRASILEIRA DE PESQUISA AGROPECUÁRIA – EMBRAPA. Manual de métodos de análise de solo.
Rio de Janeiro: Centro Nacional de Pesquisa de Solos. Rio de Janeiro, 2011. 230p.
[9] FREITAS, F. C; PRESOTTO, R. A; GENÚNCIO, G. C; SOBRINHO, N. M. B. A; ZONTA, E. pH, sódio, potássio, cálcio,
magnésio e alumínio em solos contaminados com fluido de perfuração de poços de petróleo após ensaios de lixiviação.
Ciência Rural, v. 45, n. 8, p. 1418-1423, 2015.
[10] FUKUDA, C; OTSUDO, A. A. Embrapa Mandioca e Fruticultura. Cultivo da mandioca na região centro-sul do
Brasil. [S. l], jan, 2003.
[11] FUNDAÇÃO AMAZÔNICA de AMPARO a ESTUDOS e PESQUISAS - FAPESPA. Estatísticas Municipais
Paraenses: Ácara. Belém – Diretoria de Estatística e de Tecnologia e Gestão da Informação, 2016. 12p.
[12] IBGE. Instituto Brasileiro de Geografia e Estatística. Cidades. 2010. Disponível em: <
https://cidades.ibge.gov.br>. Acesso em: 10 out. 2018.](https://image.slidesharecdn.com/topicosemcienciasagrarias-220425113627/85/Topicos-em-ciencias-agrarias-pdf-90-320.jpg)
![Tópicos em Ciências Agrárias – Volume 1
91
[13] IBGE. Produção Agrícola Municipal. 2016. Rio de Janeiro: IBGE, 2017. Disponível em: <
https://cidades.ibge.gov.br>. Acesso em: 10 out. 2018.
[14] JAKELAITIS, A; SILVA, A. A; SANTOS, J. B; VIVIAN, R. Qualidade da camada superficial de solo sob mata,
pastagens e áreas cultivadas. Pesquisa Agropecuária Tropical, v. 38, n. 2, p. 118-127, 2008.
[15] LEITE, L. F. C; GALVÃO, S. R. S; HOLANDA NETO, M. R; ARAÚJO, F. S; IWATA, B. F. Atributos químicos e
estoques de carbono em Latossolo sob plantio direto no cerrado do Piauí. Revista Brasileira de Engenharia Agrícola e
Ambiental, Campina Grande, v. 14, p. 1273-1280, 2010.
[16] MARTINS, E. C, A; PELUZIO, J. M; OLIVEIRA JUNIOR, W. P; TSAI, S. M; NAVARRETE, A. A; MORAIS, P. B.
alterações dos atributos físico-químicos da camada superficial do solo em resposta à agricultura com soja na várzea do
Tocantins. Biota Amazônica, v. 5, n. 4, p. 56-62, 2015.
[17] PREZOTTI, L. C.; MARTINS, A. G. Guia de interpretação de análise de solo e foliar. Vitória, ES: Incaper, 2013.
[18] RONQUIM, C. C. Conceitos de fertilidade do solo e manejo adequado para regiões tropicais. Campinas:
EMBRAPA monitoramento por satélite, 2010. p.30.
[19] SILVA, S. A; LIMA, J. S. S; XAVIER, A. C; TEXEIRA, M. M. Variabilidade espacial de atributos químicos de um
Latossolo Vermelho-Amarelo húmico cultivado com café. Revista Brasileira de Ciência do Solo, v. 34, n. 1, p. 15-22,
2010.
[20] SOBRAL, L. F; BARRETO, M. C. V; SILVA, A. J; ANJOS, J. L. Guia prático para interpretação de resultados de
análise de solo. Embrapa Tabuleiros Costeiros: Aracaju, 2015, 13p. (Documento, 206).](https://image.slidesharecdn.com/topicosemcienciasagrarias-220425113627/85/Topicos-em-ciencias-agrarias-pdf-91-320.jpg)



![Tópicos em Ciências Agrárias – Volume 1
95
Comparando os valores de saturação por bases e alumínio, foi constatado no presente estudo valor
elevado de saturação por alumínio de 68,18% (Cultivo de mandioca) e 14,83% (cultivo de dendê), por sua
vez foi notado valor elevado de saturação por bases de 37,85% (cultivo de dendê) e baixo de 13,73%
(Cultivo de mandioca), com isso o solo das mesmas foram classificados como distrófico por apresentar
saturação por bases menos que 50% (EMBRAPA, 2018).
Conforme explicam Veloso, Botelho e Rodrigues (2007), esses resultados são comuns em regiões tropicais
e subtropicais, seja pela ocorrência de precipitações elevadas, causando lixiviação de quantidades
apreciáveis de bases trocáveis do solo, fato comum na região amazônica, seja pela ausência de minerais
primários e secundários no solo, responsáveis pela reposição dessas bases que são lixiviadas,
consequentemente, gera baixos índices de saturação por bases e alta saturação por alumínio. Altos valores
de saturação por bases no solo também estão diretamente relacionados com a elevação do pH do solo
(FAGERIA, 2001), fato esse observado nesse trabalho.
Tabela 1. Atributos químicos do solo das culturas temporárias e perene na comunidade de Areia Branca no
município de Santa Isabel do Pará, Pará.
Parâmetros
Dendê Mandioca
Valor Interpretação¹ Valor Interpretação¹
pH (H2O) 5,3 Acidez Média 4,85 Acidez Elevada
P mg/dm³ 54,25 Alto 2,5 Baixo
K+ mg/dm³ 32 Baixo 11,5 Baixo
Ca2++Mg2+ cmolc/dm³ 1,92 Baixo 0,4 Baixo
Al3+ cmolc/dm³ 0,35 Baixo 0,9 Médio
H+ + Al3+ cmolc/dm³ 3,3 Média 2,64 Média
SB cmolc/dm³ 2,01 Médio 0,42 Baixo
CTC pH 7 cmolc/dm³ 5,31 Médio 3,06 Baixo
V % 37,85 Distrófico 13,73 Distrófico
m % 14,83 Baixo 68,18 Médio
P = Fósforo; K+ = Potássio; Ca2+ = Cálcio; Mg2+ = Magnésio; Al3+ = Alumínio trocável; H++Al3+ = Acidez potencial; SB =
Soma de Base; CTC pH7 = Capacidade de troca catiônica total; V = Saturação por base; m = Saturação por alumínio.
Fonte: (1)Dados retirados do Brasil e Cravo (2007); Prezotti e Martins (2013); Embrapa (2018).
4 CONCLUSÕES
A utilização da cultura perene como cobertura do solo melhorou ou manteve os níveis de fertilidade do
solo com maiores valores de CTC e V% em relação a cultura témporária. A cultura temporária colaborou
de forma negativa para os parâmentros de fertilidade do solo, por possível falta de manutenção e manejo
inadequado.
O sistema que mais contribui de forma sustentável foi o qual se tem a presença da cultura perene.
REFERÊNCIAS
[1] ARRUDA, M. R; MOREIRA, A.; PEREIRA, J. C. R. Amostragem e Cuidados na Coleta de Solo para Fins de
Fertilidade. Manaus: Embrapa Amazônia Ocidental, 2014. 18p.
[2] BARROS, M.N. et al. Análise espacial da dinâmica do uso da terra e cobertura vegetal do Município de Mãe do
Rio, Estado do Pará. VI Encontro Nacional da Anppas. Anais... Belém, PA, Brasil. 2012.
[3] BEZEERA, F. A. P. DECLÍNIO DA PRODUÇÃO DE MANDIOCA: OS IMPACTOS ECONÔMICOS NO MUNICÍPIO DE
SANTA IZABEL, ESTADO DO PARÁ. Agroecossistemas, v. 6, n. 1, p. 17-41, 2014.](https://image.slidesharecdn.com/topicosemcienciasagrarias-220425113627/85/Topicos-em-ciencias-agrarias-pdf-95-320.jpg)
![Tópicos em Ciências Agrárias – Volume 1
96
[4] BRASIL, E. C; CRAVO, M. S. Interpretação dos Resultados de Análise de Solo. In: CRAVO, M. S; VIÉGAS, I. J. M;
BRASIL, E. C. Recomendações de Adubação e Calagem para o Estado do Pará. Belém, 2007, p. 43-48.
[5] EMPRESA BRASILEIRA DE PESQUISA AGROPECUARIA – EMBRAPA. Manual de métodos de analise de solos.
3ed. Rio de Janeiro: Embrapa Solos, 2017. 573p.
[6] EMPRESA BRASILEIRA DE PESQUISA AGROPECUARIA – EMBRAPA. Sistema Brasileiro de Classificação do
Solo. Brasilia: DF 3.ed ver. ampl, 2013. 353p.
[7] FAGERIA, N. K. Nutrient interactions in crop plants. Journal Of Plant Nutrition, v.24, n.8, p.1269-1290, 2001.
[8] Fundação Amazônia de Amparo a Estudos e Pesquisas – FAPESPA. Estatísticas Municipais Paraenses: Santa
Izabel do Pará. Belém: Diretoria de Estatística e de Tecnologia e Gestão da Informação, 2016, 58 p.
[9] GANDAH, M. et al. Dynamics of spatial variability of millet growth and yields at three sites in Niger, west
Africa and implications for precision agriculture research. Agricultural Systems, v. 63, n. 2, p. 123-140, fev. 2000.
[10] HOMMA, A.K.O. et al. Bases para uma política de desenvolvimento da cultura do dendezeiro na Amazônia. In:
VIEGAS, I. de J.M., MÜLLER, A.A. A cultura do dendezeiro na Amazônia Brasileira. Belém: Embrapa Amazônia
Oriental/Manaus: Embrapa Amazônia Ocidental, 2000. p.11-30.
[11] JAKELAITIS, A. et al Qualidade da camada superficial de solo sob mata, pastagens e áreas cultivadas. Pesquisa
Agropecuária Tropical, v. 38, n. 2, p. 118-127, 2008
[12] LORENZI, J. O. et al. Aspectos fitotécnicos da mandioca em Mato Grosso do Sul. In: OTSUBO, A. A.; MERCANTE,
F. M.; MARTINS, C. de S. (Eds.). Aspectos do cultivo da mandioca em Mato Grosso do Sul. Dourados: Embrapa
Agropecuária Oeste/UNIDERP, 2002. p. 77-108.
[13] LORO, L.V.; CARVALHO, L.A.; NOVAK, E.; PORTILHO, I.I.R.; BRUMATTI, A.V. Caracterização de atributos
químicos do solo em diferentes sistemas de manejo. Cadernos de Agroecologia, v. 11, n. 2, 2016.
[14] MANTOVANELLI, B. C. et al. Avaliação dos atributos do solo sob diferentes usos na região de Humaitá,
Amazonas. Revista Ciência Agrária, v.58, n.2, p. 122-130, 2015.
[15] MENEZES, N.S. 2011. Fitossociologia do estrato arbóreo de um fragmento no município de Santa Izabel do
Pará- PA. Monografia apresentada ao Curso de Engenharia Florestal - Engenheiro Florestal. Universidade Federal
Rural do Rio de Janeiro. Seropédica, RJ. 2011.
[16] PAVINATO, P. S.; ROSOLEM, C. A. Disponibilidade de nutrientes no solo - decomposição e liberação de
compostos orgânicos de resíduos vegetais. Revista Brasileira de Ciência do Solo, v.32, p.911-920, 2008.
[17] PREZOTTI, L. C.; MARTINS, A. G. Guia de interpretação de análise de solo e foliar. Vitória, ES: Incaper, 2013.
[18] RAMALHO-FILHO, A. et al. Zoneamento agroecológico do dendê nas áreas desmatadas da Amazônia Legal. In:
CONGRESSO BRASILEIRO DE PLANTAS OLEAGINOSAS, ÓLEOS, GORDURAS E BIODIESEL, CLÍNICA TECNOLÓGICA EM
BIODIESEL, 2008, Lavras, MG. Biodiesel: tecnologia limpa. Anais... Lavras, MG: UFLA, 2008.
[19] VELOSO, C. A. C.; BOTELHO, S. M.; RODRIGUES, J. E. L. F. Correção da acidez do solo. In: CRAVO, M. S.; VIÉGAS,
I. J. M.; BRASIL, E. C. Recomendações de adubação e calagem para o estado do Pará. Belém, PA: Embrapa Amazônia
Oriental, 2007. p. 93-103.](https://image.slidesharecdn.com/topicosemcienciasagrarias-220425113627/85/Topicos-em-ciencias-agrarias-pdf-96-320.jpg)







![Tópicos em Ciências Agrárias – Volume 1
104
De modo geral observa-se uma tendência negativa (diminuição da precipitação) bastante expressiva e
significativa sobre grande parte as mesorregiões (dos municípios) estudas, principalmente sobre as
regiões do oeste do vale do Ipanema e do Ipojuca e do Alto Capibaribe, representados por valores
negativos do coeficiente angular. A diminuição pluviométrica ratificado neste estudo mostrou-se irregular
na escala temporal ao longo de todo o período estudado.
4 CONCLUSÃO
Constatou-se que ocorre presença de outliers em apenas dois anos, deixando os totais acima da média da
precipitação pluviométrica. Verificou-se também número maior de eventos de anos mais úmidos do em
mm/ano, para as mesorregiões do Agreste de Pernambucano.
Há uma tendência na redução da precipitação e toda a região estudada está sofrendo uma diminuição de
volume pluviométrico do período avaliado e este pode acarretar danos graves aos biomas do semiárido do
Nordeste Brasileiro, prejudicando as atividades econômicas e surgindo secas mais intensas na região. Este
trabalho reforça a necessidade de um melhor planejamento e gerenciamento de recursos hídricos por
parte de autoridades no intuito de minimizar efeitos negativos da redução do volume pluviométrico.
REFERÊNCIAS
[1] FÉLIX, D. de O., SOUSA, I. F. de, NASCIMENTO, P. J. S. da S., SANTOS, D. N. dos. Avaliação da Tendência de
Precipitação Pluviométrica anual no Estado de Sergipe. In: XVI Congresso Brasileiro de Meteorologia, Belém, 2010.
[2] GALVANI E.; LUCHIARI A. Critérios para classificação de anos com regime pluviométrico normal, seco e
úmido. Aracajú VI Simpósio Brasileiro de Climatologia Geográfica, p. 20-29, 2004.
[3] LACERDA, F. F.; DIAS, H.; ASSAD, E. D.; SANTOS, A. de. A. Detecção de Sinais de Mudanças Climáticas para
Algumas Localidades do Sertão do Pajeú - PE. In: XVI CBA - Congresso Brasileiro de Agrometeorologia, 2009, Belo
Horizonte. Mudanças Climáticas, Recursos Hídricos e Energia para uma Agricultura Sustentável, 2009.
[4] LIMA, J.S.S. de; SAMUEL DE ASSIS SILVA, S.A. de; OLIVEIRA, R.B de; CECÍLIO, R.A; XAVIER, A.C. Variabilidade
temporal da precipitação mensal em Alegre – ES. Revista Ciência Agronômica, v. 39, n. 02, p. 327-332, 2008
[5] RAMOS, A.M. Influência das mudanças climáticas devido ao efeito estufa na drenagem urbana de uma grande
cidade. Tese (Doutorado), Universidade Federal de Pernambuco – UFPE, Recife, 2010, 160p.
[6] RAMOS, Y.S.; RIBEIRO, G.N.; ALCÂNTARA, H.M. Eventos de extremos mensais da precipitação na cidade do
Recife/PE (1961-2010). Revista Verde de Agroecologia e Desenvolvimento Sustentável, (Mossoró – RN), v. 7, n. 5, p.59
– 66 , jan-dez, 2012 (Volume Especial)
[7] SANTOS, C. A. C. dos; BRITO, J. I. B. de; RAO, T. V. R.; MENEZES, H. E. A. Tendências dos índices de precipitação
no Estado do Ceará. Revista Brasileira de Meteorologia, v. 24, n. 1, p. 39-47, 2009.
[8] SCHNEIDER, H.; SILVA, C.A. da. O uso do modelo box plot na identificação de anos-padrão secos, chuvosos e
habituais na microrregião de dourados, Mato Grosso do Sul. Revista do Departamento de Geografia – USP, v. 24, p.
131-146, 2014.
[9] SILVA, R. O. B. Tendências de mudanças climáticas na precipitação pluviométrica no estado de Pernambuco.
Dissertação (Mestrado Engenharia Civil), Universidade Federal de Pernambuco – UFPE, Recife, 2013, 95p.
[10] THEIL, H. A rank-inavariant method of Linear and polynomial regression analysis, I, II, III. Nederl Akad
Wetensch Proc. 53: p. 386-392, 512-525, 1397-1412, 2000.
AGRADECIMENTOS
Agradecemos a FACEPE pelo financiamento de pesquisa, através do programa PIBIC, que concederam a
bolsa de Iniciação Científica no período 2013-2015 para a realização deste trabalho.](https://image.slidesharecdn.com/topicosemcienciasagrarias-220425113627/85/Topicos-em-ciencias-agrarias-pdf-104-320.jpg)



![Tópicos em Ciências Agrárias – Volume 1
108
Dessa forma, tem-se um cenário relevante que ações dessa natureza devem ser intensificadas pela
sociedade acadêmica, no intuito de estimular a educação e a conservação do meio ambiente, não
esquecendo que a criança é o maior disseminador em casa a partir do que aprende no ambiente escolar.
REFERÊNCIAS
[1] LEAL, I. R.; SILVA, J. M. C.; TABARELLI, M.; LANCHER JR, T. E. Mudando o curso da conservação da
biodiversidade na Caatinga do Nordeste do Brasil. Megadiversidade. V. 1, n. 1, Julho 2005.
[2] ABÍLIO, F. J. P.; FLORENTINO, H. S.; RUFF, T. L. M. Educação Ambiental no Bioma Caatinga: formação
continuada de professores de escolas públicas de São João do Cariri, Paraíba. Capa: v.5, n. 1 (2010).
[3] EMBRAPA. Agência Embrapa de Tecnologia. Bioma Caatinga. Disponível em:
http://www.agencia.cnptia.embrapa.br/gestor/bioma_caatinga/arvore/CONT000g5twgzh02wx
5ok01edq5ssfnyhwt.html>. Acesso em; 31 jan. 2017
[4] EMBRAPA. Agência Embrapa de Tecnologia. Abelhas sem ferrão, a importância da preservação, 2017
Disponível em: <http://www.cpamn.embrapa.br/apicultura/abelhasSemFerrao.php >. Acesso em: 31 jan. 2017
[5] SECRETARIA DE EDUCAÇÃO LAGOA GRANDE, 2016. http://www.lagoagrande.pe.gov.br/
[6] SECRETARIA DE EDUCAÇÃO DE SANTA MARIA DA BOA VISTA, 2016.
http://www.santamariadaboavista.pe.gov.br/secretarias/](https://image.slidesharecdn.com/topicosemcienciasagrarias-220425113627/85/Topicos-em-ciencias-agrarias-pdf-108-320.jpg)















![Tópicos em Ciências Agrárias – Volume 1
124
Em relação ao risco, todos os tratamentos tiveram risco de prejuízos acima de 50%, sendo necessário para
reverter tal situação diminuir os custos produtivos, afim de que se tenha com isso, uma melhor
atratividade. O aumento da escala de produção seria uma solução para isso, já que a área utilizada neste
estudo foi de apenas três hectares e meio.
Os resultados obtidos reforçam a importância do estudo da viabilidade econômica para fornecer ao
investidor condições para a melhor tomada de decisão, assim como para indicar a rentabilidade ou não do
negócio a ser investido.
Esta pesquisa reafirma a importância da continuação de estudos dentro do sistema de produção em
integração lavoura-pecuária-floresta, não apenas por sua comprovada viabilidade técnica e econômica,
mas também por suas contribuições à diminuição dos riscos no investimento por meio da diversificação
da produção.
Neste estudo entende-se ainda, que são necessários mais trabalhos com a ferramenta utilizada, o software
Stella, também em outras áreas de conhecimento, para que se torne uma ferramenta cada vez mais
didática e útil, auxiliando o investidor na tomada de decisão.
REFERÊNCIAS
[1] BALDEZ, A. A. T. B. Avaliação de risco da integração lavoura e pecuária, em matas de babaçu, no estado do
maranhão. 2015. 45 f. Trabalho de conclusão de curso (Graduação) – Universidade Estadual do Maranhão, São Luís,
Maranhão, 2015.
[2] EMBRAPA. Empresa brasileira de pesquisa agropecuária. Sistema de produção, Embrapa milho e Sorgo, 1. 9ª
edição. Nov. 2015.
[3] GEPLAN. Gerência de Planejamento e Desenvolvimento Econômico. Atlas do Maranhão. São Luís: UEMA/
GEPLAN, 2002. 44P.
[4] KASSAI, J. R. et al. Retorno de Investimento (Abordagem matemática e contábil do Lucro Empresarial). São
Paulo. Atlas 2005. 3º Ed. 273p.
[5] KLUTHCOUSKI, J. et al. Integração lavoura-pecuária. Santo Antônio de Goiás: Embrapa Arroz e Feijão, Ed. v. 1,
P. 443-458. 2003.
[6] LIMA JÚNIOR, V. B. Determinação na taxa de desconto para uso na avaliação de projetos de investimentos
florestais. 1995. 90 f. Dissertação (mestrado em Ciência Florestal) - Universidade Federal de Viçosa, Viçosa, MG, 1995.
[7] MAPA. MINISTÉRIO DA AGRICULTURA, PECUÁRIA E ABASTECIMENTO. Integração lavoura-pecuária.
Boletim técnico. Brasília, DF, 2007.
[8] MARANHÃO. Zoneamento Costeiro do Estado do Maranhão. Gerência de Estado de Agricultura, Pecuária e
Desenvolvimento Rural – GEAGRO, Fundação Sousândrade, Universidade Federal do Maranhão e Universidade
Estadual do Maranhão. 2003. 253p.
[9] MUNIZ, L. C. Integração lavoura-pecuária: Efeitos no solo, na forragem. Modelagem e simulação econômica.
Tese (Doutorado em Ciência Animal) pela Escola de Veterinária, Universidade Federal de Goiás, Goiânia, Goiás, 2010.
[10] MUNIZ, L. C. et al. Análise de risco da integração lavoura e pecuária com a utilização do system dynamics. In:
45º Congresso da Sociedade Brasileira de Economia, Administração e Sociologia Rural, Londrina, 2007a.
[11] MUNIZ, L. C. et al. Análise econômica da integração lavoura e pecuária com a utilização do system dynamics.
In: 45º Congresso da Sociedade Brasileira de Economia, Administração e Sociologia Rural, Londrina, 2007b.
[12] NORONHA, J. F. Projetos a agropecuários: administração financeira, orçamentos e avaliação econômica.
Piracicaba: FEALQ, 1987. 2ª ED 268p.
[13] OLIVEIRA, A. D., MACEDO, R. L. G. Sistemas agroflorestais: considerações técnicas e econômicas. Lavras, MG,
UFLA, 1996. 255p. (Projeto de consultoria).
[14] RIBEIRO, O. M. Contabilidade básica fácil. 24ª Ed. reform. São Paulo: Saraiva, 2003.
[15] SANTOS, J. C. dos; CAMPOS, R. T. Metodologia para análise de rentabilidade de riscos de sistemas
agroflorestais. Rio Branco: Embrapa Acre, 2000. 16p. (Embrapa – Acre. Documentos, 47).
[16] TOWNSEND, C. R. et al. Considerações sobre sistemas de integração lavoura-pecuária na Amazônia. Porto
Velho, RO: Embrapa Rondônia, 2009 (Série Embrapa, Documentos, 130).
[17] YOKOYAMA, L. P. et al. Avaliação econômica de técnicas de recuperação de pastagens. Editora Pillares.
Pesquisa Agropecuária Brasileira, Brasília, v. 34, n.8, 1999.](https://image.slidesharecdn.com/topicosemcienciasagrarias-220425113627/85/Topicos-em-ciencias-agrarias-pdf-124-320.jpg)













![Tópicos em Ciências Agrárias – Volume 1
138
5. CONCLUSÕES
Os custos para a produção dos cultivos solteiros foram menores nos sistemas
convencionais do que nos sistemas integrados. Apesar de levar a custos maiores, os
sistemas integrados proporcionaram maiores ganhos em produtividade,ao diluir os
custos com a alimentação animal pela pastagemconstatou-se a obtenção de uma maior
receita líquida.
A taxa de retorno e o índice de lucratividade também foram mais favoráveis aos sistemas
que utilizaram a integração (3 e 4), indicando a viabilidade econômica de tais
sistemas.Ao avaliar o indicador econômico VPL, podemos observar também melhores
resultados para os sistemas integrados, com destaque para o sistema 4.
Tais resultados reforçam a importância do estudo da viabilidade econômica para
fornecer ao investidor as condições para a melhor tomada de decisão, assim como para
indicar se o negócio proposto será rentável ou não.
Os resultados obtidos nesse estudo reafirmam a importância de se continuar a estudar
sistemas de produção integrados, não só pela sua comprovada viabilidade técnica e
econômica, mas também por suas contribuições à sustentabilidade ambiental e a
minimização dos riscos no investimento por meio da diversificação da produção, visto
sua forte competitividade com as demais opções de produção encontradas no mercado.
REFERÊNCIAS
[1] ALVES, Hellen Cristina Rodrigues; AMARAL., Renata Firmino do. Produção, área colhida e produtividade do
milho no Nordeste. Informe Rural ETENE, ano V, nº 16, set. 2011. Disponível em:
<http://www.bnb.gov.br/content/aplicacao/etene/etene/docs/ire_ano5_n16.pdf >. Acesso em: 13 dezembro de
2014.
[2] ALVES, B.; et al. Dinâmica do carbono em solos sob pastagens. In: Fundamentos da matéria orgânica do solo:
ecossistemas tropicais & subtropicais. Porto Alegre. p.561-569, 2008.
[3] BRASIL. Ministério da Agricultura, Pecuária e Abastecimento. Cadeia produtiva do milho. Brasília:
IICA/MAPA/ SPA, 2007.
[4] BRASIL. Ministério da Agricultura, Pecuária e Abastecimento. Plano setorial de mitigação e de adaptação às
mudanças climáticas para a consolidação e uma economia de baixa emissão de carbono na agricultura: plano ABC
(Agricultura de Baixa Emissão de Carbono) / Ministério da Agricultura, Pecuária e Abastecimento, Ministério do
Desenvolvimento Agrário, coordenação da Casa Civil da Presidência da República. – Brasília: MAPA/ACS, 173 p. 2012.
[5] CALLADO, A. A. C.Agronegócio: sistemas agroindustriais. 3. ed. São Paulo: Atlas, 2011.
[6] COELHO, S. T. et al. Panorama do Potencial de Biomassa no Brasil. Brasília: ANEE, 80p. 2002.
[7] CRUZ, J. C.; et. al. Produção de milho na agricultura familiar. Sete Lagoas: Embrapa Milho e Sorgo, 2011.
[8] FAO (Food and Agriculture Organization of the United Nations). Review of evidence on drylands pastoral
systems and climate change: Implications and opportunities for mitigation and adaptation. LAND AND WATER
DISCUSSION PAPER, 8.Roma,50p. 2009.
[9] GRAÇA, L. R.; RODIGHERI, H. R.; CONTO, A. J. Custos florestais de produção: conceituação e aplicação.
Documentos, 50. Colombo: Embrapa Florestas, 2000.
[10] INSTITUTO BRASILEIRO DE GEOGRAFIA E ESTATÍSTICA (IBGE). Diretoria de pesquisas, Coordenação de
Agropecuária, Pesquisa da Pecuária Municipal., 2007.
[11] KASSAI, J. R., et al. Retorno de Investimento (Abordagem matemática e contábil do Lucro Empresarial).São
Paulo. 3º ED. 273p.Atlas 2005.
[12] KATSVAIRO, T.W.; WRIGHT, D.L.; MAROIS, J.J.; HARTZOG, D.L.; RICH, J.R.; WIATRAK, P.J. Sod‑livestock
integration into the peanut‑cotton rotation: A systems farming approach. AgronomyJournal., v.98, p.1156‑1171, 2006.
[13] KLEIN, V.A. Densidade relativa: um indicador da qualidade física de um Latossolo Vermelho. Revista de
Ciências Agroveterinárias, 5:26-32, 2006.
[14] KUPFER, David. Padrões de concorrência e competitividade. In: ENCONTRO NACIONAL DA ANPEC, 20.1992,
Campos do Jordão, SP. Anais. Campos do Jordão, 1992. Uma abordagem neo-schumpeteriana da competitividade
industrial. Ensaios FEE, Rio de Janeiro, v.17, n.1, p. 355-372, 1996.](https://image.slidesharecdn.com/topicosemcienciasagrarias-220425113627/85/Topicos-em-ciencias-agrarias-pdf-138-320.jpg)
![Tópicos em Ciências Agrárias – Volume 1
139
[15] LANDAU, E. C.; GARAGORRY, L. F.; FILHO, H. C.; GARCIA, J. C.; DUARTE, CRUZ, J. C. Áreas de Concentração da
Produção Nacional de Milho no Brasil. XXVIII Congresso Nacional de Milho e Sorgo, Goiânia: Associação Brasileira de
Milho e Sorgo,2010.
[16] MAPA (Ministério da Agricultura, Pecuária e Abastecimento). Projeções do Agronegócio: Brasil 2015/2016 a
2025/2026 / Ministério da Agricultura, Pecuária e Abastecimento. Assessoria de Gestão Estratégica. – Brasília:
Mapa/ACS, 2016. 136p.
[17] MARTINS, Carlos. Plano de Negócios: Análise de Investimentos. Disponível em:<
http://www.carlosmartins.com.br/_bizplan/bizplan24.htm>. Acesso em: 19 de dezembro de 2014.
[18] MONTEVECHI, José Arnaldo Barra. Análise de Investimentos em Situações de Incerteza. Trabalho
Apresentado como Nota Parcial do Curso de MBA da UFSC. Santa Catarina, 2005.
[19] MUNIZ, L. C. Avaliação bio-econômica em sistema de integração lavoura-pecuária. Modelagem e simulação
econômica. Tese de mestrado. Universidade Federal de Goiás, Escola de Agronomia, 2007.
[20] MUNIZ, L. C. Integração lavoura-pecuária: Efeitos no solo, na forragem. Modelagem e simulação econômica.
Tese de doutorado. Universidade Federal de Goiás, Escola de Veterinária, 2010.
[21] NORONHA, J.F. Projetos a agropecuários: administração financeira, orçamentos e avaliação
econômica.Piracicaba: FEALQ, 2ª ED 268p.1987.
[22] PINHO, C. de S.; NASCIMENTO, G. C.; CAVALCANTE, m. de J. B.;Viabilidade econômica de sistemas de
produção agropecuários: metodologia e estudos de caso. 411-450 p. Brasília, DF: Embrapa, 2012.
[23] REICHERT, J.M., SUZUKI, L.E.A.S., REINERT, D.J., HORN, R., INGE HÁKANSSON, I., Reference bulk densizty and
critical degree-of-compactness for no-till crop production in subtropical highly weathered soils. SoilTill. Res., 102:242-
254, 2009.
[24] REZENDE, J. L. P.; OLIVEIRA, A. D. Análise Econômica e Social de Projetos Florestais. Viçosa, MG: UFV,389 p.
2001.
[25] RICHETTI, A.; GUIDUCCI, R. do C. N.; Viabilidade econômica de sistemas de produção agropecuários:
metodologia e estudos de caso. 477-508 p. Brasília, DF: Embrapa, 2012.
[26] SANTOS, G.A. dos; DIAS JUNIOR, M.S.; GUIMARÃES, P.T.G.; FURTINI NETO, A.E. Diferentes graus de
compactação e fornecimento de fósforo influenciando no crescimento de plantas de milho (Zeamays L.) cultivadas em
solos distintos. Ciência e Agrotecnologia, v.29, p.740-752, 2005.
[27] SILVA, M. L.; JACOVINE, L. A. G.; VALVERDE, S. R. Economia florestal. 2 ed. Viçosa, MG: UFV, 178 p. 2005.
[28] VILELA, L.; et. al. Sistemas de Integração Lavoura-Pecuária na Região do Cerrado. Pesquisa Agropecuária
Brasileira, v.46, n. 10, p.1127-1138, 2011.](https://image.slidesharecdn.com/topicosemcienciasagrarias-220425113627/85/Topicos-em-ciencias-agrarias-pdf-139-320.jpg)
